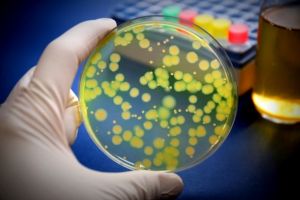
Bacil piocianic, descoperit în spitalul din Roşiorii de Vede

Ștefan Stoica (PNL Dolj): Îi solicităm domnului Prioteasa ca, alături de Consiliul Judeţean Cluj şi cel din Iaşi, să constituie Alianţa Sănătăţii!
www.oltenasul.ro - Dolj
Related Posts via CategoriesMario Ovidiu Oprea (PNL): Domnitori de lemn într-un mare regat de cioturiSenatorul PSD de Dolj, Lavinia Craioveanu: Guvernul României susţine instituirea unui mediu de afaceri durabil şi competitiv pentru promovarea femeilor în afaceri şi în poziţii de conducereMario Ovidiu Oprea (PNL): Cele două guvernări ale Cabinetului DăncilăALDE DOLJ: ACORDUL PENTRU JUSTIȚIE PROPUS DE ALDEAlina Tănăsescu, deputat PSD […]

43 de sportivi au fost premiaţi pentru rezultatele deosebite obţinute pe parcursului anului 2018, la Gala Sportului Doljean
www.oltenasul.ro - Dolj
Related Posts via CategoriesCentrul „Sfântul Nicolae” din Bucureşti al Arhiepiscopiei Craiovei organizează serbarea „Ceata Colindătorilor”Primul magazin Partener Enel deschis la CraiovaCASA RUSĂNESCU SE TRANSFORMĂ ÎN MUZEUSocietatea de Medicina Familiei Dolj: Ne aratam profund surprinsi de pozitia Directiei Patrimoniu a Primariei CraiovaMarian- Jean Marinescu: Am adus prin amendamentul meu 6 miliarde de euro în plus la TransporturiEveniment de omagiere a înaintaşilor […]

Hublou / Legătura cu viaţa
www.desteptarea.ro - Bacău
Nimeni şi nimic nu m-au împiedicat vreodată să cred în om şi în puterea lui de a construi edificii morale luminoase, de a aspira şi de a se ridica spre civilizaţie, depăşindu-şi propriile limite sau cele impuse de forţe şi împrejurări potrivnice. Sunt mulţi pesimişti la ora actuală, care spun, cu voce tare, că umanitatea …

Zăpada a blocat macazurile de cale ferată. Mai multe trenuri au întârziat zeci sau sute de minute
www.tion.ro - Timiş
Zăpada a afectat infrastructura de cale ferată din Timiş şi din zona de vest a ţării. Mai multe trenuri locale au fost afectate din cauza blocării macazurilor, iar oprirea temporară a unei garnituri a dus la întârzierea altor trenuri.

Judeţul Timiş, după o zi de cod portocaliu: peste 30 de localităţi în beznă
www.tion.ro - Timiş
Dezastru în judeţul Timiş, după o zi de cod portocaliu! 10.000 de oameni stau în întuneric în tot judeţul, pompierii au intervenit la 60 de situaţii de urgenţă, iar pe străzile din Timişoara şoferii reclamă un calvar. La deszăpezirea oraşului ies şi echipe de la societatea de termoficare Colterm.

Marşul Libertăţii, la Timişoara. Candele pe treptele Catedralei, în memoria celor căzuţi la Revoluţie
www.tion.ro - Timiş
În ziua în care a început totul, după 29 de ani, la Timişoara a avut loc Marşul Libertăţii. Revoluţionarii de la Asociaţia ALTAR au fost într-un Marş al Libertăţii, sâmbătă seară, în 15 decembrie, prin Timişoara, la 29 de ani de la izbucnirea Revoluţiei de la Timişoara.

Revoluţia din Decembrie ’89, după 29 de ani. László Tőkés: Să încercăm iarăşi să ajungem la înţelegere
www.tion.ro - Timiş
29 de ani de la Revoluţia din Decembrie 1989. Sâmbătă, în 15 decembrie, au fost depuse coroane în faţa bisericii reformate din zona Maria, locul unde a început totul... La marcarea celor 29 de ani a fost prezent şi europarlamentarul László Tőkés (în 1989 pastor reformat), care s-a referit şi la Alianţa Vestului, realizată recent de Timişoara, Cluj, Arad şi Oradea, spunând că şi acest pas „ar putea reprezenta drumul spre viitor”, spre a ajunge din nou la... înţelegere.

Accident soldat cu un rănit la Sânandrei. Circulaţie îngreunată
www.tion.ro - Timiş
O persoană a ajuns la spital, în urma unui accident care a avut loc la Sânandrei, sâmbătă după-amiază. Circulaţia în zonă este îngreunată.

Accidente, copaci căzuţi şi cabluri rupte, în timpul codului portocaliu din Timiş
www.tion.ro - Timiş
Noapte încărcată pentru pompieri, poliţişti şi medicii de pe ambulanţe din judeţul Timiş. În timpul codului portocaliu, aceştia au avut numeroase intervenţii la accidente, copaci căzuţi, cabluri de curent rupte şi pentru salvarea persoanelor fără adăpost care au rămas pe stradă.

Grav accident lângă Chevereşu Mare. Patru răniţi şi un mort
www.tion.ro - Timiş
Un grav accident de circulaţie în care au fost implicate trei autoturisme a avut loc, sâmbătă dimineaţa, lângă Chevereşu Mare, pe drumul judeţean 592. O femeie a murit, iar alte patru persoane au fost rănite.

VIDEO – Miriuţă exultă după victoria Sibiului la Mediaş – „Sunt foarte bucuros”
www.oradesibiu.ro - Sibiu
FC Hermannstadt a învins fără prea mari emoţii formaţia antrenată de Mihai Teja, Gaz Metan Mediaş. În prima parte a jocului, medieşenii nu au prea arătat nimic în teren. Cu câţiva jucători de bază în primul unsprezece în partidă cu FC Hermannstadt s-a simţit lipsa lor. Primul gol a venit…

Cad pietre pe Valea Oltului. Două maşini avariate
www.oradesibiu.ro - Sibiu
Pe Valea Oltului, la kilometrul 246, în zona podului peste pârâul Meghiş, de pe versant s-au desprins pietre. Totul s-a întâmplat sâmbătă seara. Pietrele căzut au avariat două autoturisme, unul care circula dinspre Vâlcea şi unul dinspre Sibiu. Nimeni nu a fost însă rănit. Traficul se desfăşoară îngreunat până când…

Victorie clară cu Craiova. Sibiul s-a desprins decisiv în sfertul trei
www.oradesibiu.ro - Sibiu
CSU Sibiu şi-a adăugat în palmares o victorie în urma partide de pe teren propriu cu SCMU Craiova, scor 107-82. Scorul pe sferturi a fost 29-14, 18-27, 32-22 şi 28-19. Sibienii au început cu dreptul primul sfert din Sala Transilvania, scor 29-14. Însă, sfertul secund a aparţinut echipei oaspete care…

Care sunt gratuităţile la transportul în comun din Braşov şi cine beneficiază de acestea din 2019
feedproxy.google.com - Braşov
Consiliul Local Braşov, întrunit în şedinţă deîndată, a aprobat gratutăţile pentru anul 2019, preucm şi categoriile de persoane care vor beneficia de acestea. Astfel, începând cu data de 1 ianuarie 2019 preşcolarii cu vârsta de peste 5 ani din învăţământul preşcolar şi elevii din învăţământul obligatoriu, profesional şi liceal acreditat/autorizat, şcolarizaţi în instituţiile de învăţământ

O nouă victorie la pas a voleibalistelor
www.zi-de-zi.ro - Mureş
Echipa feminină de volei CSM Târgu-Mureş a obţinut o nouă victorie la pas. Mureşencele au învins din

Bacil piocianic, descoperit în spitalul din Roşiorii de Vede
feedproxy.google.com
Bacil piocianic, descoperit în spitalul din Roşiorii de Vede - Spitalul Caritas din Roşiorii de Vede, judeţul Teleorman este suspectat că

Seria negativă a mureşencelor continuă
www.zi-de-zi.ro - Mureş
În penultima etapă a Ligii Naţionale de Baschet Feminin CSM Tîrgu-Mureş a suferit a treia înfrângere

Muzeul Sportului Mureşean
www.zi-de-zi.ro - Mureş
Ediţia din acest an a Galei Sportului Mureşean a fost precedată de inaugurarea unui Muzeu a Sportulu

Cod Galben in judetele Constanta si Tulcea. Dar si pentru tot Sud-Estul Romaniei. Mesaj de vreme severa imediata
www.ziuaconstanta.ro - Constanţa
Vant puternic in Dobrogea

Mara Poiată, pe poante spre succes
www.desteptarea.ro - Bacău
În vreme ce alţi copii, la 13 ani, visează tablete şi telefoane mobile, Mara Poiată are un alt vis; unul special în care ea străluceşte pe scenă ca balerină. Mara este elevă în clasa a VII-a la Colegiul Naţional de Artă „George Apostu” şi în ciuda faptului că este la o vârstă fragedă, are nenumărate …

SDM a aruncat 120 de tone de material antiderapant pe străzile Timişoarei
www.tion.ro - Timiş
Utilajele de deszăpezire au circulat non-stop pe străzile oraşului. Muncitorii SDM au aruncat 120 de tone de material antiderapant de vineri seară şi lucrează fără oprire cu toate forţele, ne asigură oficialii PMT.

Complet neaşteptat! Cine a fost desemnat BĂRBATUL ANULUI 2018 în România şi cât de bogat este
evz.ro - Bucureşti
Bărbatul anului 2018 este unul extrem de celebru şi bogat. A urmat Academia de Studii Economice, Facultatea de Comerţ, dar a ales să se dedice în totalitate...

IPS Teodosie va sluji, astazi, la Medgidia. La ce ora si unde
www.ziuaconstanta.ro - Constanţa
IPS Teodosie Capela Cimitir Medgidia

VIDEO&FOTO. Zăpadă pe drumurile judeţene. Utilajele nu fac faţă ninsorii abundente
portalsm.ro - Satu Mare
Ninsoare abundentă, în această seară, în judeţul Satu Mare. Zăpada s-a depus rapid pe şosele judeţene, astfel că şoferii au fost nevoiţi să circule cu viteză redusă, pentru a evita tragediile. Totodată, vizibilitatea a fost şi este în continuare redusă.

Sonda Parker: din ce in ce mai aproape de Soare!
evz.ro - Bucureşti
Sonda Parker, lansata de NASA in august 2018, a batut recordul de apropiere de Soare. Folosind materiale inovative pentru scutul termic, aceasta sonda va ef...

Liviu Dragnea pregăteşte marea lovitură. Conducerea PSD, convocată. Anunţ de ultimă oră!
evz.ro - Bucureşti
Conducerea PSD se întruneşte mâine în şedinţa Consiliului Naţional, într-o şedinţă care este în atenţia întregii clase politice din cauza implicaţiilor sal...

VIDEO: Autocar din Mureş cu 29 d epersoane răsturnat în Oltenia!
www.zi-de-zi.ro - Mureş
Pompierii Detaşamentului Slatina, cu o autospecială pentru transport personal şi victime multiple, u

TROC INEDIT de sfârşit de an. LEPTOP contra purcei
evz.ro - Bucureşti
Românii profită de orice situaţie pentru a avea carne de porc pe masa de Crăciun. Acum înainte de Sărbătorile de Iarnă sunt sute de anunţuri în care se spec...

Doua accidente mortale, in Ploiesti si Varbilau, in prima zi de iarna autentica. Doua femei si-au pierdut viata dupa ce au fost lovite de masina
ph-online.ro - Prahova
Doua accidente rutiere soldate cu decesul a doua persoane s-au produs astazi, odata cu depunerea primului strat consistent de zapada din acest an. Pri...

BC Athletic, meci nebun cu CSM Medias!: Asa incheie Gladiatorii din Tomis meciurile de acasa“
www.ziuaconstanta.ro - Constanţa
Echipa masculina de baschet Athletic Constanta a realizat astazi o victorie mare in Liga Nationala, grupa B, invingand pe teren propriu CSM Medias in ultimele secunde din prelungiri! Gazdele s-au impus ...

Dragnea, pus cu spatele la zid de Cseke Attila şi Szabó Ödön. UDMR a anunţat că nu sprijină proiectul de buget pentru 2019
www.ebihoreanul.ro - Bihor
O imagine cu Liviu Dragnea pus cu spatele la perete de Kelemen Hunor, Cseke Attila şi Szabó Ödön pare să reflecte cel mai bine poziţia Guvernului PSD-ALDE faţă de UDMR. După ce a pierdut majoritatea în Camera Deputaţilor, alianţa de guvernământ este la mâna Uniunii. De altfel, Hunor a anunţat că UDMR nu sprijină proiectul de buget pentru anul 2019. Analiştii politici spun că Dragnea va oferi UDMR intrarea la guvernare.

După faptă, şi răsplată! Moş Crăciun pune… mâna pe lopată!
expressdebanat.ro - Caraş-Severin
Iată că faptele bune se mai şi răsplătesc... După ce liberalii reşiţeni au dat la lopată în faţa sediului PSD Caraş-Severin, Moş Crăciun le-a lăsat „un cadou” chiar lângă clădirea Filialei judeţene a PNL...

Surpriză uriaşă la Kanal D! FINAL de Exalton! Cine va pleca acasă cu cei 100.000 de euro
evz.ro - Bucureşti
Exalton este acum la final. Cea de-a doua ediţie a fost mai spectaculoasă decât prima din punct de vedere al competiţiei sportive, dar a stat mai slab în au...

Încă o ţară intră în clubul atomic. Brazilia construieşte primul submarin cu propulsie nucleară
evz.ro - Bucureşti
Brazilia a lansat vinerea trecută, la Rio de Janeiro, primul submarin construit de către industria navală braziliană, care a primit numele de Riachuelo, în prezenţa preşedintelui brazilian Michel Temer şi recent alesului Preşedinte, Jair Bolsonaro....

BOMBĂ în politica românească! PNL renunţă la Klaus Iohannis. “Grupul de la Cluj” joacă tare. La două capete!
evz.ro - Bucureşti
Un scenariu incendiar a fost lansat de deputatul Remus Borza pe pagina sa de socializare. Borza afirmă că la alegerile prezidenţiale ce vor avea loc anul vi...

CUTREMUR la Guvern! DENUNȚ pentru Viorica Dăncilă. De ce este ACUZAT pemierul României
evz.ro - Bucureşti
Premierul României, Viorica Dăncilă, a fost denunţată pentru fapte din perioada în care era europarlamentar la Bruxelles....

SSC Farul Constanta s-a despartit de 12 fotbalisti
www.ziuaconstanta.ro - Constanţa
Echipa de fotbal SSC Farul Constanta a anuntat, dupa incheierea meciurilor din 2018, o analiza a celor petrecute pana cum, dar si o remaniere a lotului de jucatori. Nou promovata in Liga a 2-a s-a ...

Victorie clară cu Craiova. Sibiul s-a desprins decisiv în sfertul trei
media.oradesibiu.ro - Sibiu
CSU Sibiu şi-a adăugat în palmares o victorie în urma partide de pe teren propriu cu SCMU Craiova, scor 107-82. Scorul pe sferturi a fost 29-14, 18-27, 32-22 şi 28-19. Sibienii au început cu dreptul primul sfert din Sala Transilvania, scor 29-14. Însă, sfertul secund a aparţinut echipei oaspete care…

Pensiile în pericol! Guvernul Dăncilă în colaps! Ce urmează să se negocieze! Toţi românii sunt vizaţi
evz.ro - Bucureşti
Legea pensiilor pare o poveste fără sfârşit şi nu se ştie dacă va putea fi adoptată în forma promisă. Și asta pentru că UDMR a depus mai multe amendamente, ...

Neamţ: Două fetiţe au rămas fără mamă după accidentul din Dumbrava Roşie
www.stiri-neamt.ro - Neamţ
Două fetiţe (una de 2 ani şi 4 luni şi una de 6 ani) au rămas fără mamă după accidentul de astăzi, 15 decembrie, din Dumbrava Roşie. Diana, o tânără de 29

VIDEO – Miriuţă exultă după victoria Sibiului la Mediaş – „Sunt foarte bucuros”
media.oradesibiu.ro - Sibiu
FC Hermannstadt a învins fără prea mari emoţii formaţia antrenată de Mihai Teja, Gaz Metan Mediaş. În prima parte a jocului, medieşenii nu au prea arătat nimic în teren. Cu câţiva jucători de bază în primul unsprezece în partidă cu FC Hermannstadt s-a simţit lipsa lor. Primul gol a venit…

Tiberiu Pirnau: Ziarul de Valcea merge mai departe dupa ce a fost sabotat cibernetic!
ziaruldevalcea.ro - Vâlcea
Ceea ce nu ne doboara, cu siguranta ne face mai puternici! Le MULTUMIM tuturor prietenilor care ne-au sustinut moral si specialistilor IT care s-au implicat in remedierea problemelor tehnice de la …

DEZASTRU în România! 13.000 de familii ÎN PERICOL din cauza VREMII SEVERE. Se iau măsuri DE URGENȚĂ
evz.ro - Bucureşti
Viscolul puternic a afectat România, sâmbătă, lăsând 13.000 de familii în beznă, numai în judeţul Buzău....
![60 de intervenţii în judeţul Timiş! Accidente, copaci căzuţi şi localităţi fără curent! Echipajele de deszăpezire din Timişoara nu fac faţă! [VIDEO]](/showimg/300-200--zi/images/fullinfo.ro-images/news-287910.jpg)
60 de intervenţii în judeţul Timiş! Accidente, copaci căzuţi şi localităţi fără curent! Echipajele de deszăpezire din Timişoara nu fac faţă! [VIDEO]
expressdebanat.ro - Caraş-Severin
Pompierii din cadrul ISU Banat au intervenit în 60 de cazuri de situaţii de urgenţă în ultimele 12 ore. Cinci accidente au avut loc în judeţul Timiş, mai mulţi copaci au fost degajaţi de pe străzi şi autoturisme şi au avut loc şi trei incendii. La ora 20.00, 31 de localităţi nu erau alimentate cu energie electrică parţial sau chiar total. Cele mai multe intervenţii au avut loc în Timişoara, unde se circulă cu dificultate şi la această oră.

Octavian Bellu, cel mai titrat antrenor din lume. Care este planul SECRET după pensionare
evz.ro - Bucureşti
La vârsta de 67 de ani, cel mai titrat antrenor de gimnastică din lume, Octavian Bellu este pensionar. Se simte încă în putere şi participă ca multe acţiuni...

De unde a luat Vuza bani pentru a cumpăra Oltchim
ziaruldevalcea.ro - Vâlcea
Chimcomplex Borzeşti, companie deţinută de omul de afaceri Ştefan Vuza, a făcut public de unde a obţinut banii pentru a cumpăra cele mai importante active ale combinatului chimic Oltchim Râmnicu Vâ…

Arhiepiscopia Ramnicului: Colinde şi cărţi copiilor din casele de tip familial ale Fundaţiei Inimă pentru inimă din Parohia Trăstari!
ziaruldevalcea.ro - Vâlcea
Cu binecuvântarea Înaltpreasfinţitului Părinte Varsanufie, Arhiepiscopul Râmnicului, joi, 13 decembrie, elevii clasei a VIII-a E, de la Școala Gimmazială „Take Ionescu”, din Râmnicu -Vâlcea, coord…

Numărul de telefon la care puteţi verifica starea drumurilor judeţene din Timiş, pe timp de iarnă
www.tion.ro - Timiş
Se circulă în continuare în condiţii de iarnă pe drumurile din Timiş. Potrivit autorităţilor, nu există drumuri judeţene cu circulaţia blocată sau închisă. Trebuie însă să circulaţi cu prudenţă, deoarece există sectoare cu polei. Aveţi la dispoziţie un număr de telefon unde vă puteţi informa despre starea drumurilor judeţene sau puteţi face sesizări legate de starea drumurilor!
![De toată jena! Maşinile de deszăpezire au rămas înzăpezite la Lugoj! [VIDEO]](/showimg/300-200--zi/images/fullinfo.ro-images/news-287905.jpg)
De toată jena! Maşinile de deszăpezire au rămas înzăpezite la Lugoj! [VIDEO]
expressdebanat.ro - Caraş-Severin
Căderile masive de zăpadă din ultimele ore, dar şi slaba gestionare a situaţiei din partea administraţiei lugojene au generat sâmbătă seara imagini de tot râsul în municipiul timişean, cu maşini ce trebuiau să îndepărteze zăpada, rămase blocate în mijlocul drumului. Mai mult, pentru ca tabloul să fie complet, unul dintre cele patru utilaje aflate pe…

Înaltpreasfinţitul Părinte Varsanufie s-a rugat împreună cu actorii la sărbătoarea Sfântului Mucenic Filimon
ziaruldevalcea.ro - Vâlcea
Înaltpreasfinţitul Părinte Varsanufie, Arhiepiscopul Râmnicului, a săvârşit la Catedrala Arhiepiscopală, vineri, 14 decembrie, zi în care Biserica Ortodoxă îl pomeneşte pe Sfântul Mucenic Filimon, …

„Colinde şi cântece pentru bunicii noştri” la Căminul pentru persoane vârstnice din Râmnicu-Vâlcea
ziaruldevalcea.ro - Vâlcea
Cu binecuvântarea Înaltpreasfinţitului Părinte Varsanufie, Arhiepiscopul Râmnicului, miercuri, 12 decembrie, la Căminul pentru persoane vârstnice din Râmnicu-Vâlcea s-a desfăşurat acţiunea „Colinde…

FOTO, LIVE VIDEO: Concert extraordinar de colinde tradiţionale româneşti, la Casa de Cultură a Sindicatelor din Alba Iulia
ziarulunirea.ro - Alba
Sâmbătă, 15 decembrie 2018, de la ora 18,00, la Casa de Cultură a Sindicatelor din Alba Iulia are loc un program extraordinar de colinde tradiţionale româneşti. În cadrul concertului vor evolua numeroşi artişti care vor aduce în faţa publicului albaiulian tradiţiile şi obiceiurile de iarnă, într-un aranjament muzical special realizat de Alexandru Pal. „Ca în …

Tromboliza – tratamentul salvator în caz de AVC. Reduce la minim efectele
feedproxy.google.com
Cei care au suferit un atac cerebral vascular vor putea face tromboliză, la Spitalul Judeţean Constanţa. Aceasta constă în injectarea unei substanţe, care dizolvă cheagul format pe vasul de sânge. Aplicat la cel mult 5 ore de producerea unui accident vascular cerebral, tratamentul reduce la minim efectele secundare ale AVC-ului. Medicii din cadrul secţiei Neurologie …

Remus Borza, BOMBA ANULUI! Declaraţii EXPLOZIVE despre demisia din Parlament
ziaruldevalcea.ro - Vâlcea
// // „Multe persoane mă întreabă de ce am intrat în politică. E o întrebare legitimă, deoarece s-a creat o anumită percepţie despre politică şi, implicit, despre politicieni. Evident, una negativă…

FOTO: Frumuseţea fabuloasă a Apusenilor şi a oamenilor de pe munte, în imagini alb-negru, într-o călătorie din 1964
ziarulunirea.ro - Alba
Povestită şi ilustrată de inginerul şi fotograful Viorel Mihai Simionescu, o excursie în Apuseni în anul 1964, surprinde farmecul peisajului în imagini alb-negru, dar şi greutăţile şi lipsurile locuitorilor de aici. Povestea călătoriei începe în oraşul Cîmpeni, „trece“ pe la Gheţarul de la Scărişoara şi se termină în zona carstică Padiş. Autorul imaginilor avea în …

Cad pietre pe Valea Oltului. Două maşini avariate
media.oradesibiu.ro - Sibiu
Pe Valea Oltului, la kilometrul 246, în zona podului peste pârâul Meghiş, de pe versant s-au desprins pietre. Totul s-a întâmplat sâmbătă seara. Pietrele căzut au avariat două autoturisme, unul care circula dinspre Vâlcea şi unul dinspre Sibiu. Nimeni nu a fost însă rănit. Traficul se desfăşoară îngreunat până când…

Atenţie! Poliţia română arde bani. Sute de milioane într-o singură zi. VIDEO
evz.ro - Bucureşti
Atenţie! Poliţia română arde bani. Sute de milioane într-o singură zi. VIDEO...

FOTO: Bărbat prins după ce a recoltat ilegal trufe
www.gorjeanul.ro - Gorj
Poliţiştii, jandarmii şi reprezentanţi ai Direcţiei Silvice Gorj au continuat, ieri, acţiunea Scutul Pădurii, pe raza comunei Peştişani. În timpul controalelor a fost depistat un tânăr de 23 de ani, din municipiul Deva, judeţul Hunedoara, care a recoltat aproape patru kilograme de tru

Emoţii mari pentru Valentina Pelinel! EVENIMENTUL care a COPLEȘIT-O. Îşi va AMINTI mult timp de acest lucru - FOTO
evz.ro - Bucureşti
Cristi Borcea şi Valentina Pelinel a participat de curând la un eveniment extrem de important şi emoţionant. ...

Emoţii mari pentru Valentina Pelinel! EVENIMENTUL care a COPLEȘIT-O. Îşi va AMINTI mult timp de acest lucru - FOTO
evz.ro - Bucureşti
Cristi Borcea şi Valentina Pelinel a participat de curând la un eveniment extrem de important şi emoţionant. ...

Legea care face LINIŞTE în toată ţara. Amenzile sunt URIAŞE
evz.ro - Bucureşti
Un proiect de lege care în prezent este la preşedintele Klaus Iohannis pentru promulgare prevede ca orice petrecere privată care deranjează vecinii va putea...

VIDEO EMOȚIONANT: Căţei salvaţi de pe munte de jandarmi gorjeni
www.gorjeanul.ro - Gorj
Misiune cu final fericit, astăzi, în zona montană Rânca, unde jandarmii au reuşit să salveze mai mulţi căţei din zăpadă. Animalele au fost duse la sediul postului montan.Salvăm suflete când turiştii sunt în siguranţă la munte. As

Descoperire ULUITOARE. Un celebru fotbalist este imaginea traficanţilor de droguri
evz.ro - Bucureşti
În timpul unei percheziţii la adresele unor traficanţi de droguri din Marsilia, jandarmii din Bouches-du-Rhone au găsit mai multe pachete de mici dimenşiuni...

ULTIMA ORĂ! Legea pensiilor în pericol! UDMR nu vrea să voteze! Guvernul Dăncilă în colaps! Ce urmează să se negocieze! Toţi românii sunt vizaţi
evz.ro - Bucureşti
Legea pensiilor pare o poveste fără sfârşit şi nu se ştie dacă va putea fi adoptată în forma promisă. Și asta pentru că UDMR a depus mai multe amendamente, ...

ALERTĂ! Un autocar PLIN CU PASAGERI s-a răsturnat. Informaţii de ULTIMĂ ORĂ
evz.ro - Bucureşti
Un autocar plin cu pasageri s-a răsturnat, sâmbătă seara, pe un drum judeţean din Olt....

SCM Poli va lupta din nou pentru Cupa României. Handbaliştii timişoreni s-au calificat în Final Four cu victoria de la Baia Mare
expressdebanat.ro - Caraş-Severin
SCM Poli a câştigat cu 28-26 după aruncările de departajare în partida din sferturile Cupei României, jucată pe terenul lui Minaur Baia Mare. Lupta a fost strânsă, iar după 60 de minute, scorul a fost 24-24, iar Ludovic Varo a fost eroul alb-violeţilor, după ce a apărat două aruncări de la 7 metri şi astfel,…

FOTO. Râul Mureş, populat pe raza municipiului Alba Iulia, cu 1000 de kg de crap românesc
ziarulunirea.ro - Alba
Râul Mureş a fost populat, sâmbătă, pe raza municipiului Alba Iulia, cu 1.000 de kilograme de crap românesc, în urma unui protocol încheiat între primărie şi Asociaţia Judeţeană a Vânătorilor şi Pescarilor Sportivi (AJVPS) Alba. Încă o acţiune de populare cu peşte a râului Mureş a fost realizată de către AJVPS Alba în colaborare cu …

Rectificare de buget cu discuţii, în Consiliul Local Reghin
www.zi-de-zi.ro - Mureş
Consilierii reghineni, întruniţi în ultima şedinţă ordinară din acest an, au avut pe ordinea de zi

TRAGEDIE! Un tramvai A DERAIAT. Sunt zeci de VICTIME, unele încarcerate
evz.ro - Bucureşti
Un tramvai a deraiat pe una dintre străzile din Lisabona, provocând rănirea a zeci de persoane. Unele victime au rămas prinse între fiarele contorsionate, p...

Lovitură de teatru! S-a aflat cine sunt de fapt ADEVĂRAȚII fondatori ai noului partid, PLUS, al lui Dacian Cioloş
evz.ro - Bucureşti
Dacian Cioloş a tot oscilat între partide, iar acum după eşecul MRÎ (Mişcarea România Împreună) şi-a construit PULS (Partidul Libertăţii, Unităţii şi Solida...

Băutura MIRACULOASĂ cu efect DETOXIFIANT. Beneficiile sunt INCREDIBILE
evz.ro - Bucureşti
Combinaţia dintre aceste două ingrediente poate reduce nivelul de colesterol din sânge, poate stimula circulaţia şi poate desfunda arterele înfundate. Acest...

FOTO&VIDEO. Oraş de poveste. Atmosferă superbă în centrul Sătmarului
portalsm.ro - Satu Mare
Oraş de poveste. Atmosferă superbă în centrul Sătmarului

FOTO&VIDEO. Oraş de poveste. Atmosferă superbă în centrul Sătmarului
portalsm.ro - Satu Mare
Oraş de poveste. Atmosferă superbă în centrul Sătmarului

Liberalii reşiţeni au pus mâna pe lopeţi, să le crape obrazul pesediştilor!
expressdebanat.ro - Caraş-Severin
Doi dintre cei mai activi liberali din echipa dinamicului primar Nelu Popa pare că au vrut să dea azi o lecţie pesediştilor. În plin cod portocaliu de ninsori, Hadrian Popescu şi Andrei Apostol s-au fotografiat lopătând zăpada din faţa sediului PSD Caraş-Severin.

Cioloş are, în sfârşit, partid: „Vrem să construim o Românie care să fie pe PLUS!”
www.ebihoreanul.ro - Bihor
Fostul premier tehnocrat Dacian Cioloş a anunţat naşterea unei nou formaţiuni politice: PLUS, Partidul Libertăţii, Unităţii şi Solidarităţii, pe care, însă, după ce a eşuat în încercarea de a-şi înregistra propria formaţiune bazată pe Mişcarea România Împreună, blocată de contestaţii la Tribunalul Bucureşti, l-au înregistrat câţiva colaboratori. Cioloş spune că exista riscul ca aceasta să nu primească în timp util undă verde de la instanţă pentru a fi eligibil în alegerile europarlamentare, aşa că îşi invită susţinătorii să intre în PLUS.

Alertă! Microb FOARTE PERICULOS depistat în România! Medicii nu ştiu ce să facă!
evz.ro - Bucureşti
Alertă! Microb FOARTE PERICULOS depistat în România! Medicii nu ştiu ce să facă!...

METEO: Avertizare imediată în judeţul Neamţ (15 decembrie). Viscol puternic în zona de munte
www.stiri-neamt.ro - Neamţ
Administraţia Naţionala de Meteorologie a emis o avertizare imediată (nowcasting), pentru urmatoarele zone din judeţul Neamţ: COD GALBEN Valabil până la:

Proteste de AMPLOARE în Italia. Acuzaţii GRAVE împotriva vicepremierului Matteo Salvini. Care sunt cerinţele manifestanţilor
evz.ro - Bucureşti
Ca urmare a ordonanţei de urgenţă emisă de ministrul de Interne Matteo Salvini, care este şi vicepremier şi lider al Ligii (extrema dreaptă) prin care anule...

Care sunt gratuităţile la transportul în comun din Braşov şi cine beneficiază de acestea
feedproxy.google.com - Braşov
Consiliul Local Braşov, întrunit în şedinţă deîndată, a aprobat gratutăţile pentru anul 2019, preucm şi categoriile de persoane care vor beneficia de acestea. Astfel, începând cu data de 1 ianuarie 2019 preşcolarii cu vârsta de peste 5 ani din învăţământul preşcolar şi elevii din învăţământul obligatoriu, profesional şi liceal acreditat/autorizat, şcolarizaţi în instituţiile de învăţământ

Laboratorul „Dacia”, tradiţia dulce a prăjiturilor
www.zi-de-zi.ro - Mureş
Reghinul nu duce lipsă de tradiţii, fie că vorbim de prelucrarea lemnului sau alte ramuri ale indust

Neamţ: Val de accidente în judeţul Neamţ (VIDEO)
www.stiri-neamt.ro - Neamţ
Ninsoarea şi vremea rea au făcut victime pe şoselele din judeţul Neamţ. Cel mai grav a fost accidentul din Dumbrava Roşie, unde o tânără de 29 de ani a

DESCOPERIRE ISTORICĂ! Arheologii sunt ULUIȚI: „Este excepţional de bine conservat”
evz.ro - Bucureşti
O nouă descoperire senzaţională a fost făcută în Egipt. Argeologii au scos la iveală un mormânt aparţinând unui preot, vechi de peste 4000 de ani....

Cum să înmulţeşti banii familiei. Metodă testată
evz.ro - Bucureşti
Cum să înmulţeşti banii familiei. Metodă testată...

VIDEO Trafic blocat la Tălmaciu după un accident cu două maşini
www.oradesibiu.ro - Sibiu
Traficul este blocat sâmbătă seara pe DN7, în zona tălmaciu după ce s-a produs un accident soldat cu trei răniţi. Vinovat de producerea lui este un şofer de 19 ani care circula dinspre Tălmaciu spre Tălmaciu 2. A intrat pe contrasens şi s-a izbit de un alt autoturism care circula…

VIDEO Victorie de aur pentru FC Hermannstadt la Mediaş. Ne apropiem de play off
www.oradesibiu.ro - Sibiu
Echipa lui Vasile Miriuţă s-a impus sâmbătă seară cu 0-2 în meciul jucat în deplasare în derbiului judeţului Sibiu din liga 1. Tătar şi Stoica au adus victoria obţinută în fieful lui Gaz Metan. Sibiul a jucat perfect în faţa Mediaşului. Dâlbea & co au avut o sete mare de…

Imagini de la eveniment:"Oricine poate fi Mos Craciun". Show total la meciul caritabil de baschet de la Constanta (galerie foto)
www.ziuaconstanta.ro - Constanţa
Sala Sporturilor din Constanta a gazduit in aceasta seara editia a doua a meciului caritabil de baschet MK All Stars NATO Forces - Phoenix Stiinta Constanta. Organizata de CS Phoenix Stiinta sub ...

FOTO ȘTIREA TA: Drumuri ca-n Evul Mediu, pe străzile Șesuri şi Abrudului, din cartierul albaiulian Miceşti. Gropi, mizerie, noroi în loc de trotuare şi stradă asfaltată
ziarulunirea.ro - Alba
Străzi ca-n Evul Mediu, pe străzile Șesuri şi Abrudului, din cartierul albaiulian Miceşti. Gropi, mizerie, noroi în loc de trotuare şi stradă asfaltată! Gropi, mizerie, noroi în loc de trotuare şi stradă asfaltată, de asta au parte zeci de familii care locuiesc pe străzile Abrudului şi Șesuri, cartierul Miceşti, din municipiul Alba Iulia. Locuitorii „Oraşului …

TRAGEDIE pe şosea. Un român a fost lăsat să moară după ce a fost CĂLCAT cu maşina
evz.ro - Bucureşti
Trupul unui bărbat decedat a fost găsit pe o şosea din localitatea Arluno, Italia. Potrivit Poliţiei italiene, bărbatul de 35 de ani era de naţionalitate ro...

Christina Aguilera va sustine un recital de Anul Nou in Times Square
ziarmm.ro - Maramureş
Cantareata Christina Aguilera va sustine un recital live in fata unui public de aproape un milion de persoane care se vor reuni in seara de Anul Nou in emblematica piata Times Square, cu cateva minute

Doar cu rugăciuni nu se poate juca rugby. Timişoara Saracens pierde din nou un meci la „masa verde” şi se alege cu altă amendă de la EPCR!
expressdebanat.ro - Caraş-Severin
De ruşine în 2017, de ruşine şi în 2018! Campioana României Timişoara Saracens a rămas din nou corigentă la organizarea unui meci de Challenge Cup. Dacă în 2017 bănăţenii au pierdut la „masa verde” din cauza unui teren îngheţat cu Stade Francais, în decembrie 2018, echipa românească a fost „sabotată” de ninsoare în faţa englezilor…

De ce femeile se ÎNGRAŞĂ mai UŞOR decât bărbaţii?
evz.ro - Bucureşti
Conform unei cercetărI, femeile şi bărbaţii au o structură a creierului diferită şi reacţionează altfel la hormonul Pro-opiomelanocortin (POMC), care joacă...

Legea pensiilor. Anunţ NEAȘTEPTAT de la Guvern. MUTARE BOMBĂ înainte de votul final
evz.ro - Bucureşti
Legea pensiilor se va negocia cu UDMR, după ce formaţiunea maghiară a depus o serie de amendamente, despre care Guvernul a spus iniţial că nu le poate susţi...

TRAGEDIE la Zizin. Cum un băieţel de 10 ani şi-a pedepsit bunica. Familia este DISTRUSĂ
evz.ro - Bucureşti
Locuitorii din localitatea Zizin au fost uluiţi când au auzit ce s-a întâmplat în urmă cu câteva zile. Un băieţel de 10 ani nu a mai vrut să meargă la şcoal...

Nicolae Bădălău, declaraţie ULUITOARE la Ministerul Economiei despre INDUSTRIA de APĂRARE
evz.ro - Bucureşti
Ministrul Economiei Niculae Bădălău, a declarat, la întâlnirea cu reprezentanţii sindicatelor din industria naţională de apărare, că politicile orientate d...

Scene incredibile într-un mare oraş din România. Ce au făcut drumarii în plin cod galben de ninsori. Video!
evz.ro - Bucureşti
Scene incredibile într-un mare oraş din România. Ce au făcut drumarii în plin cod galben de ninsori. Video!...

VIDEO Victorie de aur pentru FC Hermannstadt la Mediaş. Ne apropiem de play off
media.oradesibiu.ro - Sibiu
Echipa lui Vasile Miriuţă s-a impus sâmbătă seară cu 0-2 în meciul jucat în deplasare în derbiului judeţului Sibiu din liga 1. Tătar şi Stoica au adus victoria obţinută în fieful lui Gaz Metan. Sibiul a jucat perfect în faţa Mediaşului. Dâlbea & co au avut o sete mare de…

Diana şi Ioana, câştigătoarele concursului ”Eu iubesc Reghinul”
www.zi-de-zi.ro - Mureş
Copiii reghineni, cu vârsta până la 10 ani inclusiv, au fost protagoniştii concursului de desene i

Acuzaţii GRAVE împotriva Microsoft. ALERTĂ pentru TOŢI utilizatorii. Descoperirea este INCREDIBILĂ
evz.ro - Bucureşti
După ce un utilizator de Reddit a observat că toată activitatea de pe Windows este stocată într-un cloud, a dat totul publicităţii. Windows a recunoscut că ...

Reacţia Episcopiei Greco – Catolice de Oradea la achitarea Preasfinţitului Virgil Bercea: Adevărul a fost confirmat de justiţie!
www.ebihoreanul.ro - Bihor
Episcopia Greco - Catolică Oradea a anunţat, sâmbătă, prin intermediul purtătorului de cuvânt Mihaela Caba-Madarasi, că decizia de achitare a Preasfinţitului Virgil Bercea este „o confirmare a adevărului din partea organelor de justiţie”, şi vine după o perioadă în care episcopul s-a confruntat cu probleme majore de sănătate. „Sperăm că vestea confirmării nevinovăţiei sale va contribui la însănătoşirea totală”, a transmis purtătorul de cuvânt.

VIDEO Trafic blocat la Tălmaciu după un accident cu două maşini
media.oradesibiu.ro - Sibiu
Traficul este blocat sâmbătă seara pe DN7, în zona tălmaciu după ce s-a produs un accident soldat cu trei răniţi. Vinovat de producerea lui este un şofer de 19 ani care circula dinspre Tălmaciu spre Tălmaciu 2. A intrat pe contrasens şi s-a izbit de un alt autoturism care circula…

ALERTĂ în spitale! A fost găsită o bacterie EXTREM de PERICULOASĂ şi rezistentă la ANTIBIOTICE. ANUNȚ CLAR al ministrului Sănătăţii
evz.ro - Bucureşti
Ministrul Sănătăţii a lansat sâmbătă un semnal de alarmă extrem de grav, susinând că în spitalul din Roşiorii de Vede s-a descoperit o bacterie extrem de pe...

Marcel Vela i-a ridicat statuie lui Brian Filimon. În Senatul României!
expressdebanat.ro - Caraş-Severin
Senatorul liberal de Caraş-Severin Marcel Vela reuşeşte săptămânal să strecoare câte un moment de laudă adus primarilor cărăşeni liberali în plenul şedinţei Senatului. De această dată a venit rândul comunei Măureni, senatorul declarând că executivul comunei Măureni a sculptat timpul şi va rămâne în istoria locului.

TRAGEDIE la Zizin. Cum băieţel de 10 ani şi-a pedepsit bunica. Familia este DISTRUSĂ
evz.ro - Bucureşti
Locuitorii din localitatea Zizin au fost uluiţi când au auzit ce s-a întâmplat în urmă cu câteva zile. Un băieţel de 10 ani nu a mai vrut să meargă la şcoal...

Scandal monstru! O celebră cântăreaţă riscă ÎNCHISOAREA!
evz.ro - Bucureşti
Scandal monstru! O celebră cântăreaţă riscă ÎNCHISOAREA!...

Lapte ecologic, cu proprietăţi terapeutice, care să te facă să dormi mai uşor, lansat pe piaţă de o firmă din Alba
ziarulunirea.ro - Alba
Lapte ecologic, cu proprietăţi terapeutice, care să te facă să dormi mai uşor, lansat pe piaţă de o firmă din judeţul Alba! Farmacistul Mihai Miron (57 ani), proprietarul Bioterra Doştat, intenţionează să lanseze pe piaţă un nou produs de nişă: lapte ecologic, lapte cu proprietăţi terapeutice, un lapte care să te facă să dormi mai …

Patru tone de droguri confiscate distruse de poliţişti zilele trecute. Valorau peste 625 milioane lei
www.oradesibiu.ro - Sibiu
Nu mai puţin de patru tone de droguri cotate la o valoare de peste 625 de milioane de lei au fost distruse de Poliţie Română în zilele de 13-14 decembrie. Printre stupefiantele incinerate s-a numărat şi cea mai mare captură de cocaină din 2016, de 2,5 tone. Drogurile au fost…

Iarna face probleme în ţară – Maşini blocate şi persoane afectate în mai multe judeţe
www.oradesibiu.ro - Sibiu
Ninsorile care s-au abătut în ultimele 24 ore au afectat nu mai puţin de şapte judeţe. În evenimentele produse de vremea rea au fost implicate 12 maşini şi 24 persoane, anunţă Inspectoratul General pentru Situaţii de Urgenţă. Potrivit sursei citate, la nivel naţional, în ultimele 24 de ore, vremea a…

Zece destinaţii turistice din Europa care merită vizitate în această iarnă
www.oradesibiu.ro - Sibiu
Unele locuri din Europa sunt mai potrivite pentru a fi vizitate vara, însă alte destinaţii turistice, nu trebuie ratate în timpul iernii, potrivit The Telegraph. 1. Parcul Naţional Riisitunturi, Finlanda Înfiinţat în 1982, în Posio, în apropiere de graniţa cu Rusia, se întinde pe o suprafaţă de 77 de kilometri…

VIDEO ȘTIREA TA: Șosea acoperită cu zăpadă şi trafic îngreunat pe DN75, între Câmpeni şi Lupşa
ziarulunirea.ro - Alba
Carosabil acoperit cu zăpadă şi trafic îngreunat! Aceasta este povestea care se repetă în fiecare iarnă atunci când ninge, pe drumurile din Apuseni, necurăţate de zăpadă. Cei care au avut de suferit sunt, în special, şoferii. Zăpada dă din nou bătăi de cap şoferilor care, în fiecare an, în această perioadă întâmpină aceaşi problemă: drumuri …

Ortodocşii ruşi nu se vor mai ruga la Muntele Athos. Decizie ISTORICĂ a preşedintelui Ucrainei, Petro Poroşenko
evz.ro - Bucureşti
Decizia prin care Biserica Ortodoxă din Ucraina a luat-o de a se rupe de Biserica Ortodoxă Rusă a creat un val de nemulţumiri în rândul conducerii acesteia ...

PSD A PIERDUT încă un lider important. DOLIU ÎN POLITICĂ.
evz.ro - Bucureşti
Un consilier local din PSD a murit. Politicianul lipsise de la ultimele şedinţe ale Consiliului Local, iar colegii săi de partid au anunţat că este bolnav...

Șah la Arena Mall
www.desteptarea.ro - Bacău
Astăzi a avut loc cea de a doua ediţie a competiţiei de şah de la Arena Mall. Ediţia aceasta a fost cu atât mai importantă, cu cât invitatul special a fost preşedintele Federaţiei Române de Șah -Sorin Iacoban. “Salut evenimentul de la Bacău şi îmi doresc ca asemeni Iaşului, să ajungeţi şi aici la un …

LIVE VIDEO & TEXT Gaz Metan – FC Hermannstadt. Toate detaliile de la Mediaş!
www.oradesibiu.ro - Sibiu
Sâmbătă, 15 decembrie 2018, FC Hermannstadt joacă pe terenul celor de la Gaz Metan Mediaş, într-un meci ce contează pentru etapa cu numărul 20 a Ligii întâi. În partidă din tur, Sibiul a pierdut la limită partidă cu Gaz Metan, scor 0-1, graţie reuşitei lui Valentin Creţu. Ora de Sibiu…

Cea mai grea ninsoare din România. A nins enorm
www.oradesibiu.ro - Sibiu
Mereu spunem că iarna ne-a luat pe nepregătite. Și asta atunci când ninge câteva ore. De-a lungul vremii, însă, în România au fost ierni cu adevărat grele. Poate cea mai dificilă a fost în 1954, când troienele ajungeau la câţiva metri înălţime, după ce a nins zile în şir. Cea…

METEO: ANM a actualizat avertizarea meteo de ninsori
www.stiri-neamt.ro - Neamţ
Administraţia Naţională de Meteorologie (ANM) a actualizat atenţionarea meteo de ninsori, lapoviţă, ploi şi polei, valabilă până dumincă, 16 decembrie,

Vremea. Meteorologii AVERTIZEAZĂ: fenomenul PERICULOS va lovi curând. Dezastru din cer
evz.ro - Bucureşti
Un fenomen extrem de periculos denumit „freezing rain” („ploaie îngheţată”), va avea loc în Marea Britanie. Meteorologii au emis deja avertizări pentru nins...

La un sanctuar dedicat elefantilor varstnici din Thailanda, pahidermele se relaxeaza pe acorduri muzicale
ziarmm.ro - Maramureş
La un sanctuar dedicat elefantilor varstnici din Thailanda, pahidermele se relaxeaza pe acorduri muzicale, a informat Reuters vineri, potrivit Agerpres. De opt ani, elefantii in varsta, suprasolicitat

Avertisment dur. Legea care scoate România in Europa. Riscăm să ratăm tot
evz.ro - Bucureşti
Avertisment dur. Legea care scoate România in Europa. Riscăm să ratăm tot...

Întreruperi de energie electrică în opt localităţi cărăşene. Cauza: viscolul şi ninsorile abundente de astăzi
expressdebanat.ro - Caraş-Severin
Echipele de intervenţie ale E- Distribuţie Banat sunt pe teren în zonele afectate de ninsoarea şi viscolul din ultimele ore. Probleme apărute în opt localităţi cărăşene.

Întreruperi de energie electrică în opt localităţi cărăşene. Cauza: viscolul şi ninsorile abundente de astăzi
expressdebanat.ro - Caraş-Severin
Echipele de intervenţie ale E- Distribuţie Banat sunt pe teren în zonele afectate de ninsoarea şi viscolul din ultimele ore. Probleme apărute în opt localităţi cărăşene.

DEZASTRUL venit din cer. Meteorologii AVERTIZEAZĂ. Fenomenul PERICULOS cuprinde toată ţara
evz.ro - Bucureşti
Un fenomen extrem de periculos denumit „freezing rain” („ploaie îngheţată”), va avea loc în Marea Britanie. Meteorologii au emis deja avertizări pentru nins...

Cine uită, e complice! Timişoara, la 29 de ani de la Revoluţia din ’89. Programul manifestărilor
www.tion.ro - Timiş
În urmă cu 29 de ani, Timişoara dădea startul revoluţiei care a scăpat România de comunism. Revoluţionarii au început încă de vineri să marcheze momentele din Decembrie 1989. Vor fi marşuri pentru eroi, depuneri de coroane, lansări de carte sau proiecţii de film şi chiar concerte, pe parcursul mai multor zile. Vedeţi ce program au pus la punct asociaţiile de revoluţionari şi primăria!

DEZASTRUL venit din cer. Meteorologii AVERIZEAZĂ. Fenomenul PERICULOS cuprinde toată ţara
evz.ro - Bucureşti
Un fenomen extrem de periculos denumit „freezing rain” („ploaie îngheţată”), va avea loc în Marea Britanie. Meteorologii au emis deja avertizări pentru nins...

Neamţ: A decedat una dintre victimele accidentului de la Dumbrava Roşie
www.stiri-neamt.ro - Neamţ
Una dintre victimele accidentului de astăzi, 15 decembrie, din Dumbrava Roşie, a decedat la Spitalul Judeţean de Urgenţă din Piatra-Neamţ. Conform unor

VIDEO Femeie jefuită într-un restaurant fast-food din Sibiu
www.oradesibiu.ro - Sibiu
O femeie din Sibiu a fost jefuită într-un fast-food din oraş chiar în timp ce aceasta mânca. Scenă a fost surprinsă de camerele de supraveghere din restaurant. Vedem în imagini cum o femeie, însoţită de alte trei persoane, dar şi de doi copii, se îmbracă şi vrea să plece din…

Cea mai grea ninsoare din România. A nins enorm
media.oradesibiu.ro - Sibiu
Mereu spunem că iarna ne-a luat pe nepregătite. Și asta atunci când ninge câteva ore. De-a lungul vremii, însă, în România au fost ierni cu adevărat grele. Poate cea mai dificilă a fost în 1954, când troienele ajungeau la câţiva metri înălţime, după ce a nins zile în şir. Cea…

LIVE VIDEO: Concert extraordinar de colinde tradiţionale româneşti, la Casa de Cultură a Sindicatelor din Alba Iulia
ziarulunirea.ro - Alba
Sâmbătă, 15 decembrie 2018, de la ora 18,00, la Casa de Cultură a Sindicatelor din Alba Iulia are loc un program extraordinar de colinde tradiţionale româneşti. În cadrul concertului vor evolua numeroşi artişti care vor aduce în faţa publicului albaiulian tradiţiile şi obiceiurile de iarnă, într-un aranjament muzical special realizat de Alexandru Pal. „Ca în …

SCANDALUL din maternităţile bucureştene ia amploare. Decizie RADICALĂ a ministrului Sănătăţii, Sorina Pintea
evz.ro - Bucureşti
Ministrul Sănătăţii, Sorina Pintea a efectuat mai multe controale în maternităţile private şi de stat din Capitală. În urma acestor controale Sorina Pintea ...

Cum va arăta Cetatea Alba Iulia în anul 2118, în viziunea elevilor câştigători ai concursului Naţional Minecraft pentru Educaţie
ziarulunirea.ro - Alba
Cum va arăta Cetatea Alba Iulia atunci când românii vor sărbători 200 de ani de când a luat fiinţă România Mare? În anul 2118, Cetatea Alba Carolina şi situl arheologic din Alba Iulia vor avea un muzeu modern Minecraft, sală de istorie, sală de arte plastice. Aşa şi-au închipui elevii câştigători ai primei ediţii a …

Procurorii au găsit un suspect în cazul orădencei găsită ucisă în apartament. Bărbatul a fost arestat pentru omor şi tâlhărie
www.ebihoreanul.ro - Bihor
Criminalul orădencei de 68 de ani, găsită moartă în seara zilei de 3 decembrie într-un apartament de bloc din cartierul Velenţa, a fost prins, iar la solicitarea procurorilor de la Parchetul de pe lângă Tribunalul Bihor, instanţa a dispus arestarea individului pentru o perioadă de 30 de zile.

Un bebelus si mama lui, scosi din nameti si transportati la spital de jandarmi
www.ziuaconstanta.ro - Constanţa
Un bebelus in varsta de o luna si mama acestuia au fost scosi din nameti de jandarmii din cadrul Inspectoratului de Jandarmi Judetean Prahova, care actionau la degajarea drumului DN 1D - Ciorani - ...

Momentul TERIFIANT în care o fetiţa CADE ÎN GOL de la etajul cinci. Cum au salvat-o doi bărbaţi - VIDEO DRAMATIC
evz.ro - Bucureşti
Incident dramatic, într-un orăşel din Rusia, surprins de camerele de supraveghere. O fetiţă de şase ani a căzut în gol de la etajul al cincilea al apartamen...

Odraslă de traficant de droguri, după gratii. Și-a aflat pedeapsa la un an după ce a „şifonat” un poliţist în trafic.
evz.ro - Bucureşti
În primăvara anului trecut, a luat pe capotă un poliţist care a vrut să îl amendeze în trafic. Acum plăteşte pentru neghiobia de atunci cu nu mai puţin de o...

A TREIA opţiune de GEN, pentru certificatele de naştere, a fost APROBATĂ IERI în parlamentul Germaniei
evz.ro - Bucureşti
Germania a adoptat ieri o modificare a legii care permite oamenilor să opteze pentru o a treia opţiune de gen pe formele oficiale. Bundestagul a transmis vi...

TRISTEȚE mare în politica românească! Un alt LIDER din PSD s-a stins din viaţă. Reacţia colegilor de partid
evz.ro - Bucureşti
Un consilier local din PSD a murit. Politicianul lipsise de la ultimele şedinţe ale Consiliului Local, iar colegii săi de partid au anunţat că este bolnav...

Cioloş a dat LOVITURA VIEȚII! Dragnea, luat prin surprindere! Scena politică se schimbă radical
evz.ro - Bucureşti
Cioloş a dat LOVITURA VIEȚII! Dragnea, luat prin surprindere! ...

FOTO, VIDEO: Fuego, spectacol de poveste, în Parcul sărbătorilor de iarnă din Cetatea Alba Carolina
ziarulunirea.ro - Alba
Paul Surugiu – Fuego, un brand al Crăciunului românesc, un adevărat fenomen, Artist al Poporului Republicii Moldova şi unul dintre cei mai iubiţi artişti român, a susţinut sâmbătă, un spectacol de poveste la Alba Iulia, în Parcul sărbătorilor de iarnă din Cetatea Alba Carolina. Spectacolul face parte dintr-un turneu eveniment dedicat iernii, spiritului românesc şi …

A murit băiatul de 10 ani care a încercat să se spânzure ca să nu meargă la şcoală
feedproxy.google.com - Braşov
Un copil de 10 ani, din localitatea Zizin, care a încercat să se spânzure în locuinţa sa, după ce bunica l-a trimis la şcoală, a murit, sâmbătă, după cinci zile, la Spitalul de Copii din Braşov, unde fusese ţinut în viaţă cu ajutorul aparatelor. Surse medicale au declarat, pentru Mediafax, că băieţelul de 10 ani,

Săgeţi OTRĂVITE la Exatlon. „Nu mi-a plăcut de Ana, nu am suportat-o”
evz.ro - Bucureşti
Concurenta Mariana Nenu este cunoscută ca fiind o femeie extrem de ambiţioasă, o luptătoare în adevăratul sens al cuvântului. De când a venit la Exatlon a d...

Teleorman: Bacterie extrem de periculoasă, găsită pe lenjeria din spital, depistată şi la un pacient
evz.ro - Bucureşti
Piocianic, o bacterie extrem de periculoasă găsită pe lenjeria Spitalului din Roşiorii de Vede, judeţul Teleorman, a fost depistată şi în corpul unui pacien...

Ialomiţa: Autoturisme rămase înzăpezite
obiectiv.net - Ialomiţa
Ca urmare a manifestării fenomenelor meteorologice nevaforabile, care au condus la depunerea de polei sau zăpadă, în zona de nord-vest... Vezi tot

Diplome de apreciere pentru cadrele UMFST Târgu-Mureş
www.zi-de-zi.ro - Mureş
Liga Studenţilor din Târgu-Mureş a organizat miercuri, 12 decembrie, în cadrul Zilelor UMFST, evenim

VIDEO Femeie jefuită într-un restaurant fast-food din Sibiu
media.oradesibiu.ro - Sibiu
O femeie din Sibiu a fost jefuită într-un fast-food din oraş chiar în timp ce aceasta mânca. Scenă a fost surprinsă de camerele de supraveghere din restaurant. Vedem în imagini cum o femeie, însoţită de alte trei persoane, dar şi de doi copii, se îmbracă şi vrea să plece din…

Ministrul Sorina Pintea prinsă între promisiuni şi ameninţări. Sindicaliştii din Sănătate ameninţă cu GREVA GENERALĂ
evz.ro - Bucureşti
Federaţia Solidaritatea Sanitară a anunţat că va declanşa grevă de avertisment şi ulterior chiar grevă generală în cazul în care Guvernul va îngheţa salarii...

Ialomiţa: 11 linii electrice afectate de vântul puternic. Izolatori sparţi şi conductori rupţi.
obiectiv.net - Ialomiţa
Din cauza condiţiilor meteo deosebite (cod galben de vânt puternic), au fost afectate reţelele electrice din raza de activitate a... Vezi tot

Hercule vechi de mii de ani, găsit în locuinţa unui bărbat din Alba. Unde intenţiona bărbatul să plaseze artefactul
evz.ro - Bucureşti
Un artefact de epocă antică, reprezentând o divinitate greco–romană, susceptibil să aparţină patrimoniului cultural national, a fost recuperate de oamenii l...

Semnul decăderii lui Dragnea? DECIZIA DIN PSD are multe înţelesuri. Breaking news
evz.ro - Bucureşti
PSD a anulat prima şedinţa a CExN, care urma să aibă loc duminică, 16 decembrie, potrivit unor surse din partid. ...

Accident rutier pe bulevardul Alexandru Lapusneanu din Constanta. Victima este un pieton. Cadrele medicale chemate in ajutor
www.ziuaconstanta.ro - Constanţa
Potrivit SAJ Constanta, un accident rutier a avut loc pe bulevardul Alexandru Lapusneanu din Constanta, vis-a-vis de City. Victima accidentului este un pieton . La fata locului se afla un echipaj ...

„Audiţia” – spectacol-musical în Premieră, la Teatrul Studio
www.zi-de-zi.ro - Mureş
Duminică, 16 decembrie, de la ora 19:00, va avea loc la Teatrul Studio (Str. Köteles Sámuel nr. 6 pr

Consulul Germaniei la Sibiu, întâlnire cu studenţii germani de la UMFST
www.zi-de-zi.ro - Mureş
Consulul Republicii Federale Germania la Sibiu, Excelenţa Sa Hans E. Tischler, s-a aflat joi, 13 dec

DESPĂRȚIREA ANULUI în showbiz! Totul s-a întâmplat în mare SECRET. Detaliile au ieşit ACUM la iveală
evz.ro - Bucureşti
O cunoscută cântăreaţă de la noi s-a despărţit de iubitul ei, în prag de sărbători. După o relaţie de mai bine de doi ani, cei doi şi-au spus adio....

Aministia şi graţierea pe înţelesul tuturor. UN GREU DIN ZONA CSM a explicat totul foarte cla
evz.ro - Bucureşti
„Isteria publică creată de amnistie şi graţiere este un exemplu tipic despre cum discursul, ura şi intolerenţa politică pot deturna o temă care în esenţă es...

Neamţ: Poliţiştii au stabilit cum s-a petrecut accidentul în care 7 persoane au ajuns la spital
www.stiri-neamt.ro - Neamţ
Șapte persoane au ajuns la spital după un accident rutier ce a avut loc astăzi, 15 decembrie, în jurul orei 14:20, la ieşirea din Piatra-Neamţ spre Bacău,

VALEA MARE: Un bărbat a fost găsit spânzurat. Se certase cu tatăl său, care chemase poliţia
www.gazetadambovitei.ro - Dâmboviţa
Un bărbat în vârstă de 46 de ani, a fost gasit spânzurat în gradina casei din comuna Valea Mare. Bărbatul

Jaf ca-n filme! Cum a reuşit un hoţ să-i păcălească pe angajaţi
evz.ro - Bucureşti
Jaf ca-n filme! Cum a reuşit un hoţ să-i păcălească pe angajaţi...

Apariţie ŞOC la protestele de pe Champs-Elysees. VIDEO în articol
evz.ro - Bucureşti
Tensiunea creşte la Paris în cea de-a cincea sâmbătă de proteste dar, de data aceasta, nu numai din cauza vestelor galbene. Surpriza a venit din partea unui...

Un jurist acuză. „Discursul, ura şi intolerenţa politică pot deturna o temă pur juridică. Amnistia şi graţierea nu albesc juridic persoanele care au fost condamnate”
evz.ro - Bucureşti
„Isteria publică creată de amnistie şi graţiere este un exemplu tipic despre cum discursul, ura şi intolerenţa politică pot deturna o temă care în esenţă es...

Sărbători fără kilograme în plus? Natur House Reşiţa ştie cum!
expressdebanat.ro - Caraş-Severin
Sărbătorile sunt perioadele cele mai dificile pentru cei care ţin dietă. Ispite la orice pas şi, uneori, dificultatea de a opta pentru ceva sănătos pot şterge cu buretele tot efortul depus peste an pentru o siluetă de vis. Prietenii noştri de la Natur House Reşiţa au însă câteva sfaturi esenţiale pentru a trece cu bine peste sărbătorile de iarnă.

SUA: O companie aeriana ar putea sa-si alimenteze avioanele cu bicarbonat fabricat din deseuri
ziarmm.ro - Maramureş
O noua uzina din Gary, un oras din statul american Indiana, intentioneaza sa transforme sute de mii de tone de deseuri in biocarburant, iar o parte din acesta ar putea fi utilizat pentru a alimenta av

ULUITOR! Poliţiştii de la IGPR s-au filmat când distrug 600 de milioane de euro - VIDEO
ph-online.ro - Prahova
Poliţia a distrus, în perioada 13-14 decembrie, 4.000 de kilograme de droguri de risc şi de mare risc, substanţe stupefiante confiscate în dosare pena...

Primar din Prahova, ACHITAT dupa 11 ani de procese: „M-au distrus"
ph-online.ro - Prahova
Adrian Ursu a prezentat în emisiunea „Exces de putere” povestea unui fost primar al unei comune din judeţul Prahova, care a pierdut aproape tot în 11...

Ca-n poveşti şi în ultimul week-end cu spectacole din 2018, la Teatrul Colibri
www.oltenasul.ro - Dolj
Related Posts via CategoriesCASA RUSĂNESCU SE TRANSFORMĂ ÎN MUZEUCJ Dolj: Un proiect cu valoarea totală de aproape 14 milioane de euro, elaborat în parteneriat cu Ministerul Sănătăţii, a fost acceptat pentru finanţareÎn urma unor verificări efectuate de către Corpul de control al Primăriei Municipiului Craiova la spaţiile transmise în concesiune medicilor de familie au fost constatate nereguli graveE gata cantonamentul […]

Accident cu patru autoturisme la iesire din Piatra Neamt. Mai multe victime, printre care si un copil. Trei echipaje de pompieri la fata locului
www.ziuaconstanta.ro - Constanţa
Un copil in varsta de 6 ani si tanar de 19 ani au fost transportati la spital, in urma unui accident rutier petrecut, sambata, la iesire din municipiul Piatra Neamt, in care au fost implicate patru ...

DEMISIE DE RĂSUNET în politica din România. A CEDAT din cauza unui SCANDAL RUŞINOS. News alert
evz.ro - Bucureşti
Lavinia Andrei, un candidat USR la alegerile europarlamentare, a spus adio candidaturii sale după ce publicaţia online „Casa Jurnalistului” a făcut publice ...

Decizie SALVATOARE a primăriei Capitalei. Trei spitale vor fi mutate
evz.ro - Bucureşti
La ultima şedinţă, consilierii generali ai Primăriei Municipiului Bucureşti au aprobat un proiect de hotărâre pentru aaaaaaaaa...

Meteorologii au VEȘTI NOI despre vremea din Bucureşti. Ce se va întâmpla până duminică seara
evz.ro - Bucureşti
O nouă prognoză meteo pentru Bucureşti a fost emisă sâmbătă de meteorologi, valabilă până duminică, la ora 20.00....

ȘOCANT. I-a căşunat pe mama celui care l-a snopit în bătaie. Atac în miez de noapte la Gherla
evz.ro - Bucureşti
Vinerea trecută, în jurul orei 22.45, Dorina Nemeş, din Gherla, o femeie în vârstă de 53 de ani, a fost atacată din spate de un bărbat. Nu mica i-a fost sur...

Închidere circulaţie rutieră pe DJ 582 Brebu Nou – Slatina Timiş
expressdebanat.ro - Caraş-Severin
Prin prezenta, Direcţia de Drumuri Judeţene Caraş-Severin în calitate de administrator al drumului judeţean DJ 582 anunţă...

ULTIMĂ ORĂ: A pierdut controlul volanului şi a ajuns în şanţ
www.jurnaldevrancea.ro - Vrancea
Un accident de circulaţie a avut loc în jurul orei 15:30 pe drumul european 85, în dreptul localităţii Obrejiţa. Din cauza condiţiilor meteo, şoferul unui | Jurnal de Vrancea

IGPR: Patru tone de DROGURI de risc şi de mare risc, substanţe stupefiante confiscte în dosare penale din ultimii ani, distruse de poliţişti
ziarulunirea.ro - Alba
Poliţia Română, cu sprijinul unui operator autorizat, a distrus 4.000 de kilograme de droguri de risc şi de mare risc, substanţe stupefiante confiscate în dosare penale din ultimii ani, precizează un comunicat al IGPR. În perioada 13 – 14 decembrie a.c., Inspectoratul General al Poliţiei Române a distrus 4.000 de kilograme de droguri (cocaină, heroină, …

Vestele galbene dau un nou ASALT la Paris. Numărul MORȚILOR a crescut. MII de manifestanţi PROTESTEAZĂ - UPDATE
evz.ro - Bucureşti
Mii de protestatanţi denumiţi vestele galbene se îndreaptă către Paris, iar imagini cu marşul acestora spre capitala Franţei au fost deja difuzate de agenţi...

În sfârşit atragem fonduri europene serioase: 16 milioane de euro ajung la bugetul local
stiridegalati.ro - Galaţi
Galaţiul beneficiază de trei contracte de finanţare, în valoare de aproximativ 16 milioane de euro, pentru rambursarea cheltuielilor eligibile aferente proiectelor privind achiziţia celor 17 troleibuze noi, implementarea sistemului e-ticketing şi modernizarea străzii Traian. Primăria a reuşit să atragă la bugetul local fonduri pe apelul de proiecte ”retrospective” şi astfel să deconteze cea mai mare …

BASCHET: Doi târgovişteni au fost convocaţi la LOTUL NAȚIONAL UNDER 18!
www.gazetadambovitei.ro - Dâmboviţa
David Valentin Marcu şi Rareş Ștefan Stănescu au fost convocaţi la lotul naţional under 18, baschet masculin, în vederea pregătirii

În sfârşit atragem fonduri europene seioase: 16 milioane de euro ajung la bugetul local
stiridegalati.ro - Galaţi
Galaţiul beneficiază de trei contracte de finanţare, în valoare de aproximativ 16 milioane de euro, pentru rambursarea cheltuielilor eligibile aferente proiectelor privind achiziţia celor 17 troleibuze noi, implementarea sistemului e-ticketing şi modernizarea străzii Traian. Primăria a reuşit să atragă la bugetul local fonduri pe apelul de proiecte ”retrospective” şi astfel să deconteze cea mai mare …

În sfârşit atragem fonduri europene seioase: 16 milioane de euro ajung la bugetul local
stiridegalati.ro - Galaţi
Galaţiul beneficiază de trei contracte de finanţare, în valoare de aproximativ 16 milioane de euro, pentru rambursarea cheltuielilor eligibile aferente proiectelor privind achiziţia celor 17 troleibuze noi, implementarea sistemului e-ticketing şi modernizarea străzii Traian. Primăria a reuşit să atragă la bugetul local fonduri pe apelul de proiecte ”retrospective” şi astfel să deconteze cea mai mare …

BASCHET: Doi târgovişteni au fost convocaţi la LOTUL NAȚIONAL UNDER 18!
www.gazetadambovitei.ro - Dâmboviţa
David Valentin Marcu şi Rareş Ștefan Stănescu au fost convocaţi la lotul naţional under 18, baschet masculin, în vederea pregătirii

BASCHET: Doi târgovişteni au fost convocaţi la LOTUL NAȚIONAL UNDER 18!
www.gazetadambovitei.ro - Dâmboviţa
David Valentin Marcu şi Rareş Ștefan Stănescu au fost convocaţi la lotul naţional under 18, baschet masculin, în vederea pregătirii

Donaţie UMFST. Peste 500 de cărţi au ajuns la Casa de Copii „Sf. Iosif” din Odorheiu Secuiesc!
www.zi-de-zi.ro - Mureş
Universitatea de Medicină, Farmacie, Știinţe şi Tehnologie (UMFST) din Târgu-Mureş şi Liga Studenţil

COD PORTOCALIU de vreme grea, ninsori abundente şi voscol. În Caraş-Severin zeci de localităţi au rămas fără curent electri
evz.ro - Bucureşti
De sâmbătă dimineaţă judeţele Caraş-Severin si Timiş, dar si zona de munte a judeţelor Hunedoara, Mehedinţi, Gorj, Vâlcea, Argeş, Dâmboviţa şi Prahova se vo...

Păcatele COSTĂ. Candidata USR la europarlamentare, al cărei fiu a publicat fotografii nud cu fosta sa iubită, şi-a dat demisia din partid. „Condamn hărţuirea de orice fel”
evz.ro - Bucureşti
Lavinia Andrei, un candidat USR la alegerile europarlamentare, a spus adio candidaturii sale după ce publicaţia online „Casa Jurnalistului” a făcut publice ...

ALERTĂ la graniţă! Un avion de luptă s-a PRĂBUȘIT. Ultimele informaţii despre TRAGEDIA AVIATICĂ
evz.ro - Bucureşti
Un avion de luptă ucrainean s-a prăbuşit sâmbătă după-amiază, în timp ce executa manevre de aterizare. Pilotul aparatului de zbor a decedat....

Cioloş SCHIMBĂ STRATEGIA din mers. Decizie radicală a fostului premier. ÎI VA IEŞI MUTAREA? Breaking news
evz.ro - Bucureşti
Nimeni nu îl credea pe Cioloş un om versat în ale politicii, dar fostul premier a făcut la Cluj, un anunţ care arată că acesta a folosit ”castana” fierbinte...

Ce îl mai desparte pe Dragnea de eşecul suprem? Duşmanii îi cântă Prohodul. Breaking news în politică
evz.ro - Bucureşti
Ludovic Orban a declarat sâmbătă, într-o emisiune televizată, că demiterea Guvernului Dăncilă se află în mâinile UDMR şi ALDE, explicând că, dacă cele două ...

Ungaria ne-a dat lovitura. România este scoasă din joc.
evz.ro - Bucureşti
Ungaria ne-a dat lovitura. România este scoasă din joc. ...

CASA RUSĂNESCU SE TRANSFORMĂ ÎN MUZEU
www.oltenasul.ro - Dolj
Related Posts via CategoriesÎn urma unor verificări efectuate de către Corpul de control al Primăriei Municipiului Craiova la spaţiile transmise în concesiune medicilor de familie au fost constatate nereguli graveConsiliul Judeţean (CJ) Dolj a obţinut de la Ministerul Finanţelor Publice (MFP) un împrumut de 19 milioane de lei, acordat prin Trezoreria StatuluiSTART LA ÎMPODOBIT BRĂDUȚUL CU SURPRIZEVicepreşedintele Consiliului Judeţean (CJ) […]

Ministrul italian al Transporturilor le dă peste nas românilor din Ciubotă: „Sunt foarte încântat de lupta împotriva şmecherilor cu numere străine”
evz.ro - Bucureşti
Ministrul italan al Transporturilor, Danilo Toninelli, a ridicat în slăvi rezultatele decretului care interzice rezidenţilor străini să circule în Italia cu...

Cioloş a trecut la planul B. Nu mai face partidul ”Mişcarea pentru România” ci partidul ”România PLUS”
evz.ro - Bucureşti
Nimeni nu îl credea pe Cioloş un om versat în ale politicii, dar fostul premier a făcut la Cluj, un anunţ care arată că acesta a folosit ”castana” fierbinte...

Moş Crăciun a venit cu daruri la două familii din Sărata
www.desteptarea.ro - Bacău
Moş Crăciun a ajuns deja la două familii cu mai mulţi copii din comuna Sărata. Moşul a fost adus de membrii Lions Club Sf. Gheorghe Bacău, cu daruri trimise de alte două cluburi Lions din ţară, cluburile Dynamis din Timişoara şi Negru Vodă din Câmpulung Muscel. „Lions Club Sf. Gheorghe Bacău – am aflat de …

Înscrieri la „Revelionul persoanelor vârstnice”
www.zi-de-zi.ro - Mureş
Primăria municipiului Târgu-Mureş, în parteneriat cu asociaţiile persoanelor vârstnice, invită pensi

Autoturism în flăcări pe Calea Circumvalaţiunii
www.tion.ro - Timiş
Un autoturism a luat foc în trafic, sâmbătă dimineaţa, pe Calea Circumvalaţiunii din Timişoara. La faţa locului au fost chemaţi şi pompierii.

ȘELARU: 61 de porci sacrificaţi în ferma cu pestă. Autorităţile nu intervin în gospodăriile populaţiei
www.gazetadambovitei.ro - Dâmboviţa
Autorităţile au pus în executare decizia de ucidere în exploataţia comercială afectată de pesta porcină. 61 de porcine, au fost

Protestele ''vestelor galbene'' continua in Franta. Noi victime
www.ziuaconstanta.ro - Constanţa
Numarul deceselor inregistrate pe parcursul protestelor vestelor galbene , declansate la mijlocul lunii noiembrie, a crescut la sapte, au confirmat sambata pentru EFE surse oficiale, scrie Antena3.ro. ...

Uniţi pentru Maria: o fetiţă de 8 ani din Oradea, diagnosticată cu o boală gravă, are nevoie de ajutor!
www.ebihoreanul.ro - Bihor
Maria este o fetiţă din Oradea, de numai 8 ani, care are nevoie de ajutorul tuturor. Diagnosticată cu o boală necruţătoare, a plecat din oraş împreună cu părinţii săi pentru a se trata la o clinică din Paris. Fetiţa are nevoie de bani pentru a se hrăni printr-o sondă nazală, dar şi pentru a locui în Paris, orice sumă fiind binevenită.

Radiografia unui atac şocant. Cum reuşesc jihadiştii să fenteze supravegherea autorităţilor şi să comită masacre în Europa
evz.ro - Bucureşti
Ies la iveală detalii şocante despre Cherif Chekatt, autorul atentatului din Strasbourg, ale cărui acţiuni teroriste au costat viaţa a patru persoane, alte ...

Fondul de câştiguri pentru tragerea Loto 6/49 de duminică, suplimentat cu 100.000 lei
ziarulunirea.ro - Alba
Loteria Română suplimentează fondul de câştiguri pentru tragerea Loto 6/49, categoria I, care va avea loc duminică, 16 decembrie, cu 100.000 de lei, potrivit unui comunicat. La Loto 6/ 49, la categoria I, se înregistrează un report în valoare de peste 1,1 milioane lei (peste 237.000 de euro), iar la Noroc este în joc un …

Declaraţie ȘOC în PSD. Un MINISTRU se OPUNE AMNISTIEI
evz.ro - Bucureşti
Ministrul PSD al Educaţiei, Ecaterina Andronescu, a declarat că nu este de accord cu amnistierea plagiatorilor. Un profesor din comisia de drept a propus, î...

Scandal la naţionala feminină de handbal. Jucătoarele se revoltă!
evz.ro - Bucureşti
Scandal la naţionala feminină de handbal. Jucătoarele se revoltă!...

Trafic intrerupt pe DN 2B din cauza unui accident rutier. O victima. Doua autovehicule implicate
www.ziuaconstanta.ro - Constanţa
Centrul INFOTRAFIC din Inspectoratul General al Politiei Romane informeaza ca circulatia rutiera este intrerupta pe DN 2B Buzau Braila, in afara localitatii Tabarasti, judetul Buzau, din cauza ...

Neamţ: 7 victime în accidentul de astăzi, cu 4 maşini implicate (FOTO-VIDEO)
www.stiri-neamt.ro - Neamţ
Un accident rutier cu 7 victime a avut loc astăzi, 15 decembrie, în jurul orei 14:20, la ieşirea din Piatra-Neamţ spre Bacău, pe raza localităţii Dumbrava

CÂT CÂŞTIGĂ noii băieţi ai lui Augustin Lazăr? Atenţie, SUME AMEŢITOARE... Breaking news în Justiţie
evz.ro - Bucureşti
Doi magistraţi pensionari au fost angajaţi de procurorul general, Augustin Lazăr, ca şi consilieri la Parchetul General. Astfel, după cumularea pensiei cu s...

DEFLAGRAȚIE NIMICITOARE, la Tulcea. CASĂ DISTRUSĂ din cauza acumulărilor de gaze
evz.ro - Bucureşti
O femeie, de 83 de ani, din Tulcea, a ajuns la Spitalul Judeţean, rănită în urma unei deflagraţii uriaşe, produsă pe
fondul acumulărilor gaze de la butelie...

Aici SE ASCUND EXTRATEREŞTRII? Imaginea de pe Google Earth îi poate convinge pe mulţi. VIDEO viral în articol
evz.ro - Bucureşti
În timp ce privea zona Munţiilor Nevada, pe Google Earth, Tyler Glockner, unul dintre cei mai apreciaţi youtuberi care se ocupă de fenomenul OZN, a făcut o ...

Două nume grele ale handbalului românesc îl CRITICĂ pe selecţionerul Ambros Martin. „Sunt convins că nu le cunoaşte foarte bine”
evz.ro - Bucureşti
Radu Voina şi Cristian Gaţu l-au criticat pe spaniolul Ambros Martin, pentru că selecţionerul naţionalei feminine de handbal nu vorbeşte limba română. ...

Sute de utilaje de deszăpezire, pe străzile Capitalei. Cum se circulă în Bucureşti
evz.ro - Bucureşti
Sute de utilaje de deszăpezire, pe străzile Capitalei. Cum se circulă în Bucureşti...

Târg de produse hand-made în Cetate: De la cornuleţe şi broşe, până la spumantul Silvaniei în sticlă îmbrăcată în catifea (FOTO)
www.ebihoreanul.ro - Bihor
Orădenii aflaţi în criză de timp sau pană de idei cu cadourile pentru Crăciun pot trece pe la târgul hand-made din Cetate. Aici se găsesc de la cornuleţe cu rahat şi nucă, până la cremă de corp bio, fuste pictate sau spumantul Silvaniei într-o sticlă inedită, îmbrăcată în catifea.

Politist atacat cu toporul, de un barbat surprins la furat de lemn
www.ziuaconstanta.ro - Constanţa
Un barbat de 35 de ani, din municipiul Sacele, judetul Brasov, a fost arestat preventiv, sambata, dupa ce, prins in timp ce incerca sa fure paleti cu lemne, a vrut sa loveasca un politist cu ...

O bănăţeancă, numită Ambasador Elite Business Women din Cluj-Napoca
expressdebanat.ro - Caraş-Severin
Comunitatea antreprenorilor din Cluj-Napoca are un Ambasador bănăţean. Ultima ediţie din acest an a evenimentelor organizate de Elite Business Women a avut dublu rol: prin gala de final de an şi prin lansarea noului Ambasador Elite Business Women Club, la Cluj. Cu 25 de ani de experienţă în industrie, cărăşeanca Mihaela Stoica este cea care va reprezenta de acum înainte comunitatea femeilor din Ardeal.

Aici SE ASCUND EXTRATEREŞTRII? Imaginea de pe Google Earth îi poate convinge pe mulţi. VIDEO viral în articol
evz.ro - Bucureşti
În timp ce privea zona Munţiilor Nevada, pe Google Earth, Tyler Glockner, unul dintre cei mai apreciaţi youtuberi care se ocupă de fenomenul OZN, a făcut o ...

Din nou probleme cu vremea, pentru rugby-ul timişorean. Meciul cu Northampton Saints, anulat
www.tion.ro - Timiş
Pentru a doua oară, clubul Timişoara Saracens se află în situaţia de a fi nevoit să anuleze o partidă din cupele europene. După episodul cu Stade Francais, din ianuarie 2017, când meciul a fost anulat din cauza gazonului îngheţat de pe „Dan Păltinişanu”, iată că sâmbătă vremea proastă a dat din nou bătăi de cap gazdelor bănăţene, iar din cauza ninsorii meciul cu englezii de la Northampton Saints a fost anulat.

Pensionari cu VENITURI FABULOASE la Parchetul General. Cine sunt noii consilieri ai lui Augustin Lazăr
evz.ro - Bucureşti
Doi magistraţi pensionari au fost angajaţi de procurorul general, Augustin Lazăr, ca şi consilieri la Parchetul General. Astfel, după cumularea pensiei cu s...

FOTO/VIDEO. Vinerea neagră la Satu Mare. 3 accidente, 2 morţi şi mai multe persoane rănite
portalsm.ro - Satu Mare
Vinerea neagră la Satu Mare. 3 accidente, 2 morţi şi mai multe persoane rănite

Neamţ: (VIDEO) Accident grav în Piatra-Neamţ. Mai multe victime, transportate la spital
www.stiri-neamt.ro - Neamţ
Un grav accident a avut loc astăzi, 15 decembrie, în jurul orei 14:20, în municipiul Piatra-Neamţ. S-au deplasat la faţa locului 3 echipaje de pompieri cu

Secţia de Urologie a SJU Bistriţa, dotată cu echipament ESWL
www.timponline.ro - Bistriţa-Năsăud
De la începutul anului viitor, pacienţii care suferă de calculi renali vor putea fi trataţi fără intervenţie chirurgicală datorită unui echipament nou pentru Secţia de Urologie a Spitalului Judeţean de Urgenţă Bistriţa.
Este vorba de echipamentul ESWL - Extracorporeal Shock Wave Lithotripsy (lito

Volumul lucrărilor de construcţii rezidenţiale a scăzut cu 26,8%, în primele 10 luni din 2018
ziarulunirea.ro - Alba
În primele 10 luni din 2018, volumul lucrărilor de construcţii a scăzut faţă de perioada corespunzătoare a anului trecut, ca serie brută cu 4,1% şi ca serie ajustată în funcţie de numărul de zile lucrătoare şi de sezonalitate cu 2,5%, informează vineri Institutul Naţional de Statistică (INS). Pe obiecte de construcţii, volumul lucrărilor de construcţii …

VIDEO: Căţei salvaţi de pe munte de jandarmi gorjeni
www.gorjeanul.ro - Gorj
Misiune cu final fericit, astăzi, în zona montană Rânca, unde jandarmii au reuşit să salveze mai mulţi căţei din zăpadă. Animalele au fost duse la sediul postului montan.Salvăm suflete când turiştii sunt în siguranţă la munte. Astăzi, o patrulă de jandarmi montani di

Accident rutier pe DN 3. Doua autoturisme implicate
www.ziuaconstanta.ro - Constanţa
Potrivit IPJ Constanta, un accident rutier a avut loc pe DN3. Este vorba despre o coliziune intre doua autoturisme. In urma accidentului, o persoana este ranita usor. Revenim cu detalii. ...

Minunea şoferilor: preţul benzinei a coborât în weekend sub cinci lei pe litru
www.tion.ro - Timiş
Promoţia săptămânală aplicată la pompe de principalul distribuitor de carburanţi de pe piaţa românească le-a adus şoferilor timişoreni minunea de dinaintea Crăciunului. Preţul benzinei a coborât sub nivelul de cinci lei pe litru.

EXCLUSIV Scandal-monstru în Guvern: "Nişte bufoni! Nu au avut acordul meu!"
evz.ro - Bucureşti
EXCLUSIV: Ministrul Transporturilor dă de pământ cu şefii Companiei de Autostrăzi: ...

ANUNȚ de la PSD care bulversează pacienţii din România. Ce se întâmplă cu SPITALELE
evz.ro - Bucureşti
PSD a decis să amâne construirea spitalelor regionale din Iaşi, Craiova şi Cluj. Anunţul a fost confirmat de ministrul sănătăţii, Sorina Pintea, care decla...

Mai multe kilograme de tutun, ridicate de politisti in vederea confiscarii
www.ziuaconstanta.ro - Constanţa
Vineri, 14 decembrie a.c., politisti din cadrul Directiei Generale de Politie a Municipiului Bucuresti, in timpul unor verificari, au retinut un barbat, in varsta de 28 ani, din Bucuresti, dupa ce ...

FOTO-VIDEO: Mirel Rădoi, Gicu Grozav, Nicolae Stanciu şi antrenorii Licenţei A UEFA, „Împreună pentru Robert”, într-un meci caritabil!
ziarulunirea.ro - Alba
„Împreună pentru Robert”, meciul caritabil programat în Sala de Sport a Universităţii “1 Decembrie 1918” din Alba Iulia a avut o distribuţie de gală, cu nume precum Mirel Rădoi sau Gicu Grozav şi Nicolae Stanciu ce joacă fotbal din suflet pentru Robert Roman. A fost implicată în acest joc special generaţia de antrenori UEFA licenţa …

Jignire dură în PSD. Fost ministru FĂCUT DOBITOC în direct, LA TV. Breaking news
evz.ro - Bucureşti
Jurnalistul Rareş Bogdan l-a atacat extrem de dur pe Florin Iordache care s-a întrebat ce ar fi dacă s-ar dezincrimina abuzul din serviciu prin OUG. ...

Ce îl mai desparte pe Dragnea de eşecul suprem? Duşmanii îi cântă Prohodul. Breaking news în politică
evz.ro - Bucureşti
Ludovic Orban a declarat sâmbătă, într-o emisiune televizată, că demiterea Guvernului Dăncilă se află în mâinile UDMR şi ALDE, explicând că, dacă cele două ...

Premieră la teatrul Szigligeti: se va pune în scenă celebrul musical „Oliver!”
www.ebihoreanul.ro - Bihor
Musicalul „Oliver!”, adaptare a romanului „Oliver Twist” de Charles Dickens, se va pune în scenă în data de 19 decembrie la teatrul Szigligeti. În spectacol vor juca 35 de copii, 15 muzicieni şi 11 actori, iar pregătirile au început încă din mai.

Piatra-Neamţ: Accident victime încarcerate şi mai multe maşini implicate în Piatra-Neamţ
www.stiri-neamt.ro - Neamţ
Un accident grav a avut loc astăzi, 15 decembrie, în jurul orei 14:15, în municipiul Piatra-Neamţ. Din primele informaţii oferite de ISU Neamţ, în

Al Treilea Război Mondial va începe curând! Mesajul care îngrozeşte lumea. Breaking news
evz.ro - Bucureşti
Anul 2019 va aduce o catastrofă la nivel mondial, cu o creştere semnificativă a actelor de terorism, inundaţii masive, cutremure devastatoare şi izbucnirea ...

ANAF: 21 decembrie este termenul limită pentru depunerea a şapte declaraţii fiscale
obiectiv.net - Ialomiţa
Vineri, 21 decembrie, este termenul de depunere a: formularului 100 ” Declaraţie privind obligaţiile de plată la bugetul de stat”;... Vezi tot

Moş Crăciun a venit la Spitalul de Pediatrie Piteşti
ziarulargesul.ro - Argeş
Însoţit de zâne şi de oameni cu suflet mare, a adus cadouri (jucării şi fructe) micuţilor care sunt în această perioadă internaţi. Cu siguranţă cei mici ar fi preferat să-l vadă pe Moş Crăciun cu sania trasă de reni pe uliţele din satul bunicilor, dar nu-i timpul pierdut. Până la cea mai...

FOTOGALERIE: UMFStore, inaugurat la UMFST Târgu Mureş
www.zi-de-zi.ro - Mureş
La finalul Zilelor UMFST, Universitatea de Medicină, Farmacie, Știinţe şi Tehnologie din Târgu Mureş

Gest impresionant al pompierilor gorjeni
www.gorjeanul.ro - Gorj
Pompierii din Târgu-Jiu au adus, astăzi, la mal un câine blocat în mijlocul râului îngheţat. Animalul salvat a fost adoptat de angajaţii ISU Gorj. Un domn a sunat azi pe numărul unic pentru apeluri de urgenţă 112 şi semnala faptul că, pe râul Jiu, îngheţat bocnă, un câine schelăl

Controale ITM la transportatori rutieri
www.zi-de-zi.ro - Mureş
În perioada 19 - 29 noiembrie, la nivelul Inspectoratului Teritorial de Muncă (ITM) Mureş s-a desfăş

Dezastru social. Câţi tineri vor să emigreze din România. Care sunt motivele
evz.ro - Bucureşti
Dezastru social. Câţi tineri vor să emigreze din România. Care sunt motivele...

Atenţie la modul în care folosiţi cardurile bancare!
obiectiv.net - Ialomiţa
Cardul de credit sau de debit este utilizat din ce în ce mai mult în zilele noastre. Pentru protejarea acestuia... Vezi tot

Gest impresionant al pompierilor gorne o
www.gorjeanul.ro - Gorj
Pompierii din Târgu-Jiu au adus, astăzi, la mal un câine blocat în mijlocul râului îngheţat. Animalul salvat a fost adoptat de angajaţii ISU Gorj. Un domn a sunat azi pe numărul unic pentru apeluri de urgenţă 112 şi semnala faptul că, pe râul Jiu, îngheţat bocnă, un câine schelăl

ACCIDENT rutier, cu TREI VICTIME ÎNCARCERATE, la Tulcea
evz.ro - Bucureşti
Detaşamentul de pompieri ISU Tulcea a intervenit pentru descarcerarea a trei persoane încarcerate în urma unui
accident produs între Tulcea şi Agighiol...

Căţeii din rasa Husky Siberian şi musherii lor au dus faima României până departe (FOTO)
www.timponline.ro - Bistriţa-Năsăud
Cursele de atelaje canine sunt la început de drum în România, însă puţinii reprezentanţii ai ţării noastre la competiţii internaţionale, europene şi mondiale, au obţinut rezultate foarte bune. Sâmbătă, la Livezile, Clubul Sportiv Sleddog Bistriţa-Năsăud, format din Damaschin Berende, Bogdan Berende

Atenţie la escroci! Nu vă lăsaţi înşelaţi prin telefon
obiectiv.net - Ialomiţa
O femeie de 64 de ani, din comuna Cocora, a sesizat poliţia cu privire la faptul că a fost victima... Vezi tot

Patru tone de droguri confiscate distruse de poliţişti zilele trecute. Valorau peste 625 milioane lei
media.oradesibiu.ro - Sibiu
Nu mai puţin de patru tone de droguri cotate la o valoare de peste 625 de milioane de lei au fost distruse de Poliţie Română în zilele de 13-14 decembrie. Printre stupefiantele incinerate s-a numărat şi cea mai mare captură de cocaină din 2016, de 2,5 tone. Drogurile au fost…

Iarna face probleme în ţară – Maşini blocate şi persoane afectate în mai multe judeţe
media.oradesibiu.ro - Sibiu
Ninsorile care s-au abătut în ultimele 24 ore au afectat nu mai puţin de şapte judeţe. În evenimentele produse de vremea rea au fost implicate 12 maşini şi 24 persoane, anunţă Inspectoratul General pentru Situaţii de Urgenţă. Potrivit sursei citate, la nivel naţional, în ultimele 24 de ore, vremea a…

Zece destinaţii turistice din Europa care merită vizitate în această iarnă
media.oradesibiu.ro - Sibiu
Unele locuri din Europa sunt mai potrivite pentru a fi vizitate vara, însă alte destinaţii turistice, nu trebuie ratate în timpul iernii, potrivit The Telegraph. 1. Parcul Naţional Riisitunturi, Finlanda Înfiinţat în 1982, în Posio, în apropiere de graniţa cu Rusia, se întinde pe o suprafaţă de 77 de kilometri…

LIVE VIDEO & TEXT Gaz Metan – FC Hermannstadt. Toate detaliile de la Mediaş!
media.oradesibiu.ro - Sibiu
Sâmbătă, 15 decembrie 2018, FC Hermannstadt joacă pe terenul celor de la Gaz Metan Mediaş, într-un meci ce contează pentru etapa cu numărul 20 a Ligii întâi. În partidă din tur, Sibiul a pierdut la limită partidă cu Gaz Metan, scor 0-1, graţie reuşitei lui Valentin Creţu. Ora de Sibiu…

O nouă victorie pentru baschetbalistele de la CSU CSM Oradea: 65-63, pe terenul rapidistelor
www.ebihoreanul.ro - Bihor
Formaţia de baschet feminin CSU CSM Oradea a obţinut o nouă victorie în Grupa B din Liga Naţională. De această dată, bihorencele s-au impus în deplasare, la Bucureşti, pe terenul rapidistelor, cu scorul de 65-63. După o primă jumătate foarte bună, în partea a doua jocul s-a complicat pentru orădence, dar au reuşit totuşi, pe final, să-şi apropie succesul.

Baia Mare: Majorari impuse de primar. Chereches vrea zonare. 500 de lei abonamentul pentru parcarile publice din ianuarie 2019
ziarmm.ro - Maramureş
Chereches vrea sa imparta orasul in mai multe zone pe care sa le taxeze diferentiat. Aceasta zonare vizeaza locurile de parcare amenajate si marcate pe spatiul public. In acest context orasul va fi im

STRICAŢII DIN RUSIA au lovit năprasnic la final de an. Alcool, droguri şi creiere depravate. Galerie FOTO
evz.ro - Bucureşti
O serie de fotografii cu ruşi aflaţi în ipostaze mai mult decât dubioase, au fost postate pe reţelele de socializare. Bărbaţii şi femeile care apar în poze ...

STRICAŢII DIN RUSIA au lovit năprasnic la final de an. Alcool, droguri şi creiere depravate. Galerie FOTO
evz.ro - Bucureşti
O serie de fotografii cu ruşi aflaţi în ipostaze mai mult decât dubioase, au fost postate pe reţelele de socializare. Bărbaţii şi femeile care apar în poze ...

Vestele galbene, un nou ASALT la Paris. PROTESTE INEDITE în Franţa. Manifestanţi reţinuţi
evz.ro - Bucureşti
Mii de protestatanţi denumiţi vestele galbene se îndreaptă către Paris, iar imagini cu marşul acestora spre capitala Franţei au fost deja difuzate de agenţi...

Final de an pentru Academia Hagi 2010. A parasit turneul final al Memorialului Gheorghe Ene in faza grupelor
www.ziuaconstanta.ro - Constanţa
Sambata s-au disputat, la Craiova Sala Sporturilor din Isalnita , confruntarile ultimei etape din faza grupelor la turneul final al Memorialului Gheorghe Ene jucatori nascuti dupa 1 ianuarie 2010 , ...

Imagini INCREDIBILE cu Jean Claude Juncker! Preşedintele Comsiei Europene se face din nou de râs în lume! "Era beat..."/ VIDEO VIRAL
evz.ro - Bucureşti
Acuzat de mai multe ori de-a lungul timpului că ar fi venit beat la evenimente importante, printre care şi un summit NATO, Juncker s-a scuzat de fiecare dat...

FOTO: Intervenţie a edililor din Cugir pentru eliminarea efectelor cauzate de căderile de zăpadă. Administraţia dispune de utilaje şi materiale antiderapante suficiente
ziarulunirea.ro - Alba
Primăria Cugir s-a mobilizat încă de vineri seara, începând cu ora 22.00, când s-a activat comandamentul de iarnă, menit să intervină pentru decongestionarea drumurilor şi a străzilor, de prima zăpadă căzută în cursul nopţii şi de-a lungul zilei ( aprox. 5 cm în oraş si 10 – 12 cm în zona periferică) Potrivit reprezentanţilor SVSU, …

IARNA ARGEŞEANĂ, cu POLIŢIE, MASCAŢI şi POMPIERI!
ziarulargesul.ro - Argeş
Poliţia, Jandermeria, ISU şi toate instituţiile de protecţie şi intervenţie din Argeş sunt în această perioadă capacitate la maxim, pentru a asigura pe cât posibil siguranţa cetăţenilor şi de a salva ce se mai poate, în anumite cazuri. Este o siguranţă de care avem mare nevoie, fiindcă, după cum...

(FOTO) Accident teribil în Vâlcea: Doi morţi după impactul cu un camion
ziaruldevalcea.ro - Vâlcea
0 – + Doi oameni au murit, sâmbătă, pe DN 67, în localitatea Buneşti, judeţul Vâlcea, după ce un autoturism a derapat şi a lovit un camion care transporta material lemnos. În zonă ninge visco…

Victorie fără probleme pentru CSM CSU Oradea, la Bucureşti, în faţa dinamoviştilor
www.ebihoreanul.ro - Bihor
Campionii de la CSM CSU Oradea s-au impus fără probleme, vineri seara, la Bucureşti, pe terenul celor de la Dinamo Ştiinţa, în etapa a 10-a a Grupei A din Liga Naţională. După ce au controlat jocul de la început şi până la sfârşit, elevii antrenorului Cristian Achim s-au impus cu scorul de 91-77, urcând pe locul al doilea al ierarhiei la zi.

Un celebru lanţ de fast-food a dat lovitura în România! Ce plănuieşte să facă
evz.ro - Bucureşti
Un celebru lanţ de fast-food a dat lovitura în România! Ce plănuieşte să facă...

Omul puciştilor a fost eliminat! Urmărit penal şi şef de departament. Rotirea cadrelor în Guvern
evz.ro - Bucureşti
Fost subsecretar de stat la Ministerul Afacerilor Interne, Mihai Dan Chirică a fost numit, vineri, şef al Departamentului pentru relaţia cu Parlamentul şi c...

Peste 100 de utilaje pe drumurile din Timiş
www.tion.ro - Timiş
Judeţul Timiş a intrat sâmbătă dimineaţa sub cod portocaliu. Conform reprezentanţilor Comitetului Judeţean pentru Situaţii de Urgenţă, la această oră, în Timiş, nu există probleme deosebite pe căile de comunicaţii sau în alte domenii. Drumurile sunt deschise, dar se circulă în condiţii de iarnă.

Accident rutier pe strada Eliberarii din Constanta. Victima este un pieton. Ambulanta chemata in ajutor
www.ziuaconstanta.ro - Constanţa
In urma cu putin timp, potrivit ISU Constanta, un accident rutier a avut loc in Constanta, pe strada Eliberarii. Victima accidentului este un pieton. ...

Accident rutier pe DJ 222 intre Tulcea si Agighiol. Doua autoturisme implicate. Mai multe victime au avut nevoie de descarcerare (galerie foto)
www.ziuaconstanta.ro - Constanţa
Detasamentul de pompieri Tulcea pentru descarcerarea si acordarea primului ajutor calificat victimelor unui accident rutier produs pe DJ 222 intre localitatile Tulcea si Agighiol. Se intervine cu doua ...

Agroland pleacă în vacanţă cu o victorie şi dă o jucătoare la naţionala României
expressdebanat.ro - Caraş-Severin
UVT Agroland Timişoara s-a impus cu 3-0 în meciul din ultima etapă a turului, jucat pe terenul „lanternei roşii” CSU Belor Galaţi. Nu toate jucătoarele vor lua însă vacanţă, deoarece după acest meci, centrul Roxana Iancu se va prezenta la antrenamentele naţionalei României. Agroland a făcut deplasarea la Galaţi fără Katarina Jovanovic, deoarece sârboaica a…

Copil de 15 ani, disparut din localitatea Furnica, judetul Constanta
www.ziuaconstanta.ro - Constanţa
Politistii constanteni au fost sesizati de disparitia de la domiciliu a lui V RTEJ MARIAN COSMIN, in varsta de 15 ani, din localitatea Furnica, judet Constanta. Minorul a fost vazut ultima data pe ...

Luni, recital de pian şi vioară la Târgu-Jiu
www.gorjeanul.ro - Gorj
Școala Populară de Artă Târgu Jiu, în parteneriat cu Liceul de Arte „Constantin Brăiloiu” şi Muzeul Judeţean Gorj „Alexandru Ștefulescu”, vă invită luni, 17 decembrie, începând cu ora 17:00, la un recital de pian şi vioară.Cursanţii clasei de pian şi vioară, coordonaţi

Accident rutier mortal pe DJ 592. O persoana decedata si alte patru ranite. Trei autoturisme implicate
www.ziuaconstanta.ro - Constanţa
Un accident rutier, in care au fost implicate trei autoturisme, soldat cu o persoana decedata si alte patru ranite, s-a produs, sambata, pe DJ 592, in apropiere de Cheveresu Mare, scrie Agerpres.ro. ...

Premieră în Bucureşti! Avem staţii de încărcare pentru maşini electrice! Unde sunt şi cât costă
evz.ro - Bucureşti
Premieră în Bucureşti! Avem staţii de încărcare pentru maşini electrice! Unde sunt şi cât costă ...

FOTO: Târgujian mort într-un accident la Vâlcea
www.gorjeanul.ro - Gorj

FOTO, VIDEO: A venit iarna! Peisaje de basm şi drumuri acoperite de zăpadă pe Dealul Mare, spre Câmpeni
ziarulunirea.ro - Alba
A venit iarna! A început să ningă şi la munte, iar peisajele sunt de poveste pe Dealul Mare, spre Câmpeni. Drumul este acoperit de zăpadă, iar traficul se desfăşoară în condiţii de iarnă. Zăpada căzută în ultimele 24 de ore a făcut ca pe drumurile din Alba se se circule, sâmbătă, în condiţii de iarnă. …

Rotirea cadrelor în Guvern. Urmărit penal în dosarul mitingului din 10 august, a ajuns şef de departament care se ocupă de calitatea vieţii. Omul puciştilor a fost eliminat
evz.ro - Bucureşti
Fost subsecretar de stat la Ministerul Afacerilor Interne, Mihai Dan Chirică a fost numit, vineri, şef al Departamentului pentru relaţia cu Parlamentul şi c...

ASFALTARE în plină NINSOARE. Se întâmplă în ROMÂNIA. Video
evz.ro - Bucureşti
Consilierul local PNL Flavius Sirop a filmat, vineri, o echipă de muncitori care asfalta o stradă din Craiova pe ninsoare, în condiţiile în care carosabilul...

Thomas Lievremont ”contesta cu tarie” demiterea sa de pe banca tehnica a ”Stejarilor”
ziarmm.ro - Maramureş
Fostul antrenor al nationalei de rugby a Romaniei, francezul Thomas Lievremont, ''contesta cu tarie'' demiterea sa de pe banca tehnica a ''Stejarilor'', considerand ca s-a facut ''fara temei rezonabil

FOTO: Târgujieni, tată şi fiu, morţi în accident la Vâlcea
www.gorjeanul.ro - Gorj

Breaking. BENZINĂ şi MOTORINĂ la un preţ incredibil de mic. Doar în acest week-end. Unde trebuie să te duci
evz.ro - Bucureşti
Breaking. BENZINĂ şi MOTORINĂ la un preţ incredibil de mic. Doar în acest week-end. Unde trebuie să te duci...

Accident rutier cu patru victime pe DN 7C, intr-un carambol cu trei masini
www.ziuaconstanta.ro - Constanţa
Patru oameni au fost raniti, sambata, in urma unui accident rutier produs pe DN 7C, in zona localitatii argesene Merisani, circulatia intre municipiile Pitesti si Curtea de Arges fiind blocata, ...

„Frida alas para volar”, un spectacol despre Frida Kahlo, la Teatrul Ariel
www.zi-de-zi.ro - Mureş
„Un poem despre viaţa plină de dragoste şi durere a Fridei Kahlo, reprezentată prin diverse metafore

Oamenii de ştiinţă se gândesc serios la o soluţie extremă: Vom efectua experimente de geoengineering
evz.ro - Bucureşti
Oamenii de ştiinţă au decis să încerce un experiment de geoengineering. Ideea de geoengineering, este cunoscută şi sub denumirea de inginerie climatică - fo...

EPISCOPUL de Oradea, VIRGIL BERCEA, ACHITAT definitiv de INSTANȚA SUPREMĂ: „Au fost patru ani în care a murit câte puţin în sufletul lui copleşit de o ruşine pe care nu o merita”
evz.ro - Bucureşti
După aproape patru ani, timp în care numele i-a fost târât în noroi şi a trecut pe lângă moarte din cauza suferinţei
tăcute, a avut zeci de termene ...

22 de utilaje, scoase la deszăpezire pe străzile oraşului
stiridegalati.ro - Galaţi
Serviciul Public Ecosal acţionează, la acest moment, în municipiul Galaţi pentru deszăpezire cu 12 tractoare cu lamă şi perie, opt sărăriţe şi două motocultoare cu perie de un metru lăţime. Cele două motocultoare acţionează pentru deszăpezirea trotuarelor străzilor Brăilei şi Domnească, urmând să intervină şi pe cele de pe Siderurgiştilor, H. Coandă şi nu numai. …

22 de utilaje, scoase la deszăpezirea
stiridegalati.ro - Galaţi
Serviciul Public Ecosal acţionează, la acest moment, în municipiul Galaţi pentru deszăpezire cu 12 tractoare cu lamă şi perie, opt sărăriţe şi două motocultoare cu perie de un metru lăţime. Cele două motocultoare acţionează pentru deszăpezirea trotuarelor străzilor Brăilei şi Domnească, urmând să intervină şi pe cele de pe Siderurgiştilor, H. Coandă şi nu numai. …

Timişul primeşte zeci de milioane de lei din bani europeni pentru dezvoltarea serviciilor medicale
www.tion.ro - Timiş
Mai multe unităţi medicale din Timiş şi din Timişoara vor beneficia de investiţii de zeci de milioane de lei, provenind din fonduri europene. Banii vor merge spre domeniul medical, pentru dotarea unităţilor ambulatorii şi de urgenţe, dar şi pentru dotarea cu ambulanţe.

Un avion s-a prabusit. Nu au existat supravietuitori in urma impactului. Ce a dus la aceasta tragedie
www.ziuaconstanta.ro - Constanţa
O tragedie s-a produs in Mexic, scrie Romania TV. Un avion s-a prabusit foarte aproape de o zona rezidentiala. Din pacate, cei doi pasageri nu au supravietuit impactului. Autoritatile din ...

Și ei VOR CÂȘTIGA MAI MULT de la anul! Detaliul care le-a scăpat tuturor
evz.ro - Bucureşti
Încă o categorie de persoane are de câştigat după ce Guvernul a aprobat creşterea salariul minim brut de la valoarea de 1.900 de lei, cât este în prezent, l...

Kelemen Hunor a refuzat PSD: „Noi nu suntem de acord”. Dragnea este într-o situaţie delicată. Breaking news
evz.ro - Bucureşti
Kelemen Hunor a spus că, deşi proiectul de buget de stat pe anul 2019 nu a fost încă depus în Parlament, UDMR nu va susţine forma actuală de buget propusă d...

A apărut un nou club de handbal în Oradea: AS Triumph
www.ebihoreanul.ro - Bihor
Într-o perioadă în care Campionatul European de Handbal feminin din Franţa ţine capul de afiş al evenimentelor sportive din această lună, în Oradea a fost anunţată înfiinţarea unui club care doreşte să iniţieze şi să formeze tinerele în materie de acest sport, în care România excelează de mai mulţi ani.

Ofertele pentru masa de Crăciun şi cea de Revelion, la Casa Gurmandului. Locuri limitate
www.gazetadambovitei.ro - Dâmboviţa
Casa Gurmandului îşi aşteaptă, şi în acest final de an, oaspeţii la masa de Crăciun, dar şi la petrecerea dintre

Ofertele pentru masa de Crăciun şi cea de Revelion, la Casa Gurmandului. Locuri limitate
www.gazetadambovitei.ro - Dâmboviţa
Casa Gurmandului îşi aşteaptă, şi în acest final de an, oaspeţii la masa de Crăciun, dar şi la petrecerea dintre

Ofertele pentru masa de Crăciun şi cea de Revelion, la Casa Gurmandului. Ultimele locuri
www.gazetadambovitei.ro - Dâmboviţa
Casa Gurmandului îşi aşteaptă, şi în acest final de an, oaspeţii la masa de Crăciun, dar şi la petrecerea dintre

Aeroportul din Timişoara este închis din cauza zăpezii
www.tion.ro - Timiş
Aeroportul Internaţional Timişoara este închis, sâmbătă dimineaţa, din cauza zăpezii care a acoperit pista de aterizare/decolare.

Pericol nuclear la graniţele României! Rusia, implicată
evz.ro - Bucureşti
Pericol nuclear la graniţele României! Rusia, implicată...

Accident rutier intre comunele Radu Voda si Plevna. Un automobil a cazut intr-o rapa. Un copil este implicat (galerie foto)
www.ziuaconstanta.ro - Constanţa
Potrivit DRDP, un automobil a cazut intr-o rapa, intre comunele Radu Voda si Plevna, judetul Calarasi. In accident sunt implicate un barbat, o femeie si un minor. Acestia au fost transportati la ...

Tânără rănită într-un accident, la Tismana
www.gorjeanul.ro - Gorj
Evenimentul rutier a avut loc aseară, în jurul orei 18.00, în oraşul Tismana. Poliţiştii au stabilit că o şoferiţă în vârstă de 35 de ani, din localitate, nu a adaptat viteza la condiţiile de drum şi a intrat în coliziune cu un cap de pod. Oamenii legii au întocmit dosar penal pentr

Dragnea RESCRIE ISTORIA României cu o MUTARE DE NEUITAT. Un greu din Top 3 PSD a scăpat porumbelul… Breaking news
evz.ro - Bucureşti
Codrin Ștefănescu, secretarul general al PSD, susţine că, duminică nu va avea loc o şedinţă a Comitetului Executiv, ci doar şedinţa Consiliului Naţional. ...

Ce să faceţi dacă vedeţi persoane fără adăpost pe străzile Timişoarei
www.tion.ro - Timiş
Ninge fără oprire la Timişoara, e cod portocaliu de ninsori, dar meteorologii spun că temperaturile nu vor ajunge să fie negative, cel puţin pe timpul zilei. Este însă destul de frig, mai ales pentru cei care petrec ore întregi pe stradă. Dacă vedeţi persoane fără adăpost sunteţi rugaţi să le trimiteţi la centrul social al primăriei!

Zece destinaţii turistice din Europa care merită vizitate în această iarnă
info.oradesibiu.ro - Sibiu
Unele locuri din Europa sunt mai potrivite pentru a fi vizitate vara, însă alte destinaţii turistice, nu trebuie ratate în timpul iernii, potrivit The Telegraph. 1. Parcul Naţional Riisitunturi, Finlanda Înfiinţat în 1982, în Posio, în apropiere de graniţa cu Rusia, se întinde pe o suprafaţă de 77 de kilometri…

Troiţa Centenarului, sfinţită duminică la Târgu-Mureş
www.zi-de-zi.ro - Mureş
Asociaţia culturală „Dacii Liberi” organizează duminică, 16 decembrie, la slujba de Sfinţire a Troiţ

Ministrul Ecaterina Andronescu anunţă ore suplimentare pentru elevii care pierd ritmul la învăţătură, din semestrul II
ziarulunirea.ro - Alba
Ministrul Educaţiei, Ecaterina Andronescu, a anunţat că elevii începând cu clasa a III-a care pierd ritmul la învăţătură probabil vor avea ore suplimentare la şcoală pentru recuperare, începând cu semestrul II al acestui an şcolar. ”Elevii, începând de la clasa a III-a, cei care pierd ritmul cu cei care păstrează ritmul cu programa şcolară, vor …

Circulaţie în regim de iarnă în vestul ţării. Nu sunt drumuri şi căi ferate închise
www.tion.ro - Timiş
Zăpada abundentă căzută în cursul nopţii a dus la îngreunarea traficului rutier, dar nu sunt drumuri închise. La fel şi pe calea ferată se circulă, în regim de iarnă.

SOMAŢIE DE ULTIMĂ ORĂ pentru Dragnea şi Dăncilă! Situaţie critică într-un DOMENIU-CHEIE. Breaking news
evz.ro - Bucureşti
Federaţia Solidaritatea Sanitară ameninţă cu proteste, care vor culmina cu declanşarea unei greve generale, dacă Guvernul va adopta o Ordonanţă de Urgenţă p...

TRUMP obţine o VICTORIE de răsunet. OBAMA nu va uita asta cât va trăi
evz.ro - Bucureşti
Un judecător federal din statul american Texas a declarat vineri neconstituţional sistemul de asigurări medicale cunoscut ca

CUTREMUR în Guvern! Viorica Dăncilă face schimbări neaşteptate!
evz.ro - Bucureşti
CUTREMUR în Guvern! Viorica Dăncilă face schimbări neaşteptate!...

Accident rutier mortal pe DN67. O persoana a decedat si alta este ranita grav. Implicate un autotren si un autoturism
www.ziuaconstanta.ro - Constanţa
O persoana a decedat si alta a fost ranita grav, sambata, intr-un accident produs in judetul Valcea, pe DN 67, in urma coliziunii dintre un autotren si un autoturism, precizeaza Centrul Infotrafic, ...

CSU Sibiu joacă sâmbătă cu SCM U Craiova – Anunţ important pentru suporteri
www.oradesibiu.ro - Sibiu
Baschetbaliştii sibieni joacă sâmbătă, de la orele 18:00, pe teren propriu, în compania celor de la SCM Craiova, lideri ai clasamentului Ligii Naţionale de Baschet Masculin. Fanii echipei sunt rugaţi să vină la meci cu un cadou într-o cutie de pantofi, sau mai scurt, cu un ShoeBox. Ultimele bilete disponibile…

FOTO Sibiul sub cod galben de ninsoare. Cum se circulă în judeţ
www.oradesibiu.ro - Sibiu
În judeţul Sibiu a nins câteva ore bună în noaptea de vineri spre sâmbătă. Pe drumurile naţionale care străbat judeţul Sibiu drumarii au ieşit cu autospeciale de deszăpezire şi au împrăştiat material antiderapant. La această oră se circulă bine, dar în condiţii de iarnă. Sâmbătă dimineaţa pe DN 7C km…

Festival coral la Catedrala Mitropolitană din Timişoara
www.tion.ro - Timiş
La Catedrala Mitropolitană din Timişoara va avea loc festivalul coral „Leru-i, Doamne, Ler”, ediţia a IV-a. Festivalul va începe în faţa Operei din Timişoara.

VESTE-BOMBĂ din Costa Rica. Toţi se gândesc la Elena Udrea, dar... Breaking news!
evz.ro - Bucureşti
Costa Rica, deja prea cunoscută nouă din cu totul alte motive, ascunde şi alte mistere. Se pare că a fost descoperit ceea ce crede că este un oraş: o veche ...

Chereches vrea sa majoreze taxa procedurii de divort de la 500 de lei la 700 de lei
ziarmm.ro - Maramureş
Ieri, in cadrul Comisiei de Buget-Finante, alesii locali au ramas uimiti cand au vazut cu cat doreste executivul Primariei Baia Mare sa majoreze taxa pentru indeplinirea procedurii de divort, taxa car

Un şofer beat s-a oprit cu maşina în stâlp, la Târgu-Jiu
www.gorjeanul.ro - Gorj
Un tânăr de 25 de ani, din comuna Peştişani, a provocat aseară un eveniment rutier, pe strada Tismana, din Târgu-Jiu. Acesta s-a oprit cu maşina într-un stâlp. Poliţiştii au aflat şi motivul, şoferul fiind în stare de ebrietate. În urma testării cu etilotestul a rezultat o c

Pompierii, in alerta! Deblocare de usa in Constanta
www.ziuaconstanta.ro - Constanţa
Pompierii din cadrul ISU Constanta intervin in aceste momente pentru a debloca usa unui apartament. Aceste este situat pe strada Bradului numarul 1 din Constanta. ...

Iarna face probleme în ţară – Maşini blocate şi persoane afectate în mai multe judeţe
info.oradesibiu.ro - Sibiu
Ninsorile care s-au abătut în ultimele 24 ore au afectat nu mai puţin de şapte judeţe. În evenimentele produse de vremea rea au fost implicate 12 maşini şi 24 persoane, anunţă Inspectoratul General pentru Situaţii de Urgenţă. Potrivit sursei citate, la nivel naţional, în ultimele 24 de ore, vremea a…

INFO TRAFIC : Circulaţi cu atenţie pe timp de iarnă
mesageruldecovasna.ro - Covasna
Vrei să fii notificat când apare un articol nou? Abonează-te prin e-mail

A venit zăpada! Utilajele RER Vest au ieşit pe străzile Oradiei (FOTO)
www.ebihoreanul.ro - Bihor
Luna decembrie începe să semene a lună de iarnă. În noaptea de vineri spre sâmbătă, ninsoarea mult aşteptată a venit şi a îmbrăcat oraşul în alb. Muncitorii RER Vest au ieşit pe străzi încă de la ora 3 dimineaţa, iar până la ora 9 au împrăştiat pe străzi circa 360 de tone de sare.

Imagini de la eveniment: Constanta. Mos Craciun a venit la spectacolul de final de an al gimnasticii aerobice
www.ziuaconstanta.ro - Constanţa
Casa de Cultura din Constanta gazduieste astazi traditionalul spectacol de final de an Vine, vine Mos Craciun! , organizat de sectia de gimnastica aerobica a CS Farul Constanta, in parteneriat cu ...

Costa Rica, plină de mistere. Iată bomba! VIDEO în articol
evz.ro - Bucureşti
Costa Rica, deja prea cunoscută nouă din cu totul alte motive, ascunde şi alte mistere. Se pare că a fost descoperit ceea ce crede că este un oraş: o veche ...

MOMENTE GRELE pentru Andra. Tot showbizul aşteaptă REACŢIA LUI MĂRUŢĂ. A fost o veste dură pentru artistă...
evz.ro - Bucureşti
Vineri seară a avut loc finala Vocea României de la Pro Tv. Câştigătorul concursului a fost concurentul Bogdan Ioan, din echipa lui Smiley. La rândul ei, An...

Deszapezire Ploiesti. Cum arata strazile voastre? Asteptam IMAGINI
ph-online.ro - Prahova
Ph-online.ro va publica imagini cu starea carosabilului, pe masura ce acestea ne vor fi trimise la redactie de catre cititori. La aceasta ora, pe mult...

Spargere sau înscenare? Cutie cu 18.000 de lei dispărută dintr-o casă de pariuri!
portalsm.ro - Satu Mare
Spargere sau înscenare? Cutie cu 18.000 de lei dispărută dintr-o casă de pariuri!

„Bucuraţi-vă, Înalt Prea Sfinţite! A murit Stalin!”
evz.ro - Bucureşti
După instaurarea comunismului, au existat în România perioade de dezgheţ în care viaţa şi-a recăpătat farmecul. O evocare de Dan Ciachir....

OREZ CONTAMINAT. 11 morţi, alertă de sănătate publică. UNDE AU FOST raportate PRIMELE CAZURI? Breaking news
evz.ro - Bucureşti
Unsprezece persoane au murit după ce au consumat orez, contaminat probabil cu o substanţă toxică, la o ceremonie organizată într-un templu hindus din oraşul...

Urgia loveşte România. Alertă a meteorologilor. Zeci de oameni sunt deja afectaţi
evz.ro - Bucureşti
Urgia loveşte România. Alertă a meteorologilor. Zeci de oameni sunt deja afectaţi...

Patru tone de droguri confiscate distruse de poliţişti zilele trecute. Valorau peste 625 milioane lei
info.oradesibiu.ro - Sibiu
Nu mai puţin de patru tone de droguri cotate la o valoare de peste 625 de milioane de lei au fost distruse de Poliţie Română în zilele de 13-14 decembrie. Printre stupefiantele incinerate s-a numărat şi cea mai mare captură de cocaină din 2016, de 2,5 tone. Drogurile au fost…

Drumul catre Cota 1400 a fost INCHIS din cauza zapezii
ph-online.ro - Prahova
IJP Prahova a anunţat sâmbătă dimineaţă, în jurul orei 7.00, că s-a luat măsura închiderii temporare a DC 134 (drumul către cota 1400 Sinaia),...

SCANDAL NAȚIONAL la 'Vocea României': Câştigătorul s-a aflat fără niciun suspans - VIDEO
ph-online.ro - Prahova
”Vocea României”, cel mai urmărit program TV al toamnei, în România, şi-a desemnat cel de-al 8-lea câştigător! În finala de vineri seara, cei patru fi...

Șoc în lumea muzicii - Shakira a fost pusă sub acuzare pentru o fraudă fiscală de aproape 15 milioane de euro, în Spania
ph-online.ro - Prahova
Starul muzicii pop Shakira a fost pusă sub acuzare pentru fraudă fiscală în Spania, iar procuratura informează că aceasta datorează statului iberic pe...

SALVAŢI DIN ACCIDENT CU DESCARCERAREA!
ziarulargesul.ro - Argeş
Pe această vreme rea, unii şoferi fac ce fac şi se urcă la volan fără să ţină seama de condiţiile care îndeamnă la prudenţă. Astfel, Merişani a fost astăzi locul unui nou accident grav, din care au rezultat mai multe victime. Din primele date, conducătorul unui autoturism care se deplasa pe...

Cine este, de fapt, Bogdan Ioan, câştigătorul de la Vocea României, şi cum a pus mâna pe 100.000 de euro
ph-online.ro - Prahova
Bogdan Ioan a câştigat marele trofeu ”Vocea României”, de la PRO TV, şi premiul în valoare de 100.000 de euro! Pentru a treia oară, în cele 8 ediţii a...

POLIŢIŞTII au distrus 4 TONE de DROGURI confiscate în dosare PENALE
evz.ro - Bucureşti
Poliţia a distrus, în perioada 13-14 decembrie, 4.000 de kilograme de droguri de risc şi de mare risc, substanţe stupefiante confiscate în dosare penale din...

Germania: Criză acută de ”Moşi Crăciuni”
evz.ro - Bucureşti
Sărbătorile de Crăciun în Germania ar putea fi mai puţin festive, deoarece în multe regiuni există o penurie severă de ”Moşi Crăciuni”, conform agenţiilor locale de recrutare de personal....

Cum se circula in Prahova, la aceasta ora. Vezi situatia pe fiecare drum
ph-online.ro - Prahova
La aceasta ora ninge abundent in judetul Prahova, indeosebi in zona montana, unde carosabilul este acoperit de zapada. Si in Ploiesti sunt strazi pe c...

Statul Român, vinovat în cazul barmaniţei împuşcate în cap la Târgu-Mureş!
www.zi-de-zi.ro - Mureş
Judecătorii secţiei I civilă a Curţii de Apel Târgu-Mureş au decis, în data de 22 noiembrie 2018, ca

Audi căutat în Marea Britanie, confiscat la Petea
portalsm.ro - Satu Mare
Audi căutat în Marea Britanie, confiscat la Petea

FOTO: Și banchetul Olimpiei Aiud, „Împreună pentru Robert”
ziarulunirea.ro - Alba
Și banchetul Olimpiei Aiud, la final de tur, a fost tot sub egida „Împreună pentru Robert”. Echipierii formaţiei din Liga a 4-a s-au strâns la Restaurantul „Capitol” din Aiud cu gândul la coechipierul lor Adrian Roman, portarul „olimpicilor” al cărui fiu, Robert a fost diagonsticat de curând cu lucemie, micuţul urmând să aniverseze mâine, în …

GREVĂ în SĂNĂTATE. Sindicaliştii somează GUVERNUL Dăncilă
evz.ro - Bucureşti
Federaţia Solidaritatea Sanitară ameninţă cu proteste, care vor culmina cu declanşarea unei greve generale, dacă Guvernul va adopta o Ordonanţă de Urgenţă p...

Kilograme de trufe, recoltate fara acordul proprietarilor si fara autorizatie, descoperite de politisti
www.ziuaconstanta.ro - Constanţa
Ieri, politistii de ordine publica din Gorj au descoperit, in timpul unei actiuni, 4 kilograme de trufe albe si negre, culese fara acordul proprietarilor terenurilor si fara a avea autorizatie de ...

Alertă la graniţele României. A început Revoluţia! Legături suspecte cu ţara noastră
evz.ro - Bucureşti
Alertă la graniţele României. A început Revoluţia! Legături suspecte cu ţara noastră...

Tamponare la Târgu-Jiu! Un şofer a intrat cu maşina în stâlpul unui semafor
www.gorjeanul.ro - Gorj
Un autoturism s-a oprit, aseară, în stâlpul pe care era montat semaforul din apropierea Casei de Cultură din Târgu-Jiu. Șoferul a fost amendat, în urma evenimentului. În jurul orei 24.00, un bărbat care nu a adaptat viteza la condiţiile de drum a derapat şi a acroşat stâlpul se

Poveşti englezeşti, traduse de studenţii USV, pentru elevii de la Dumbrăveni
feeds.monitorulsv.ro - Suceava
Joi, 13 decembrie, la Liceul Tehnologic Mihai Eminescu din Dumbraveni a avut loc lansarea volumului 3 povesti englezesti, carte ce cuprinde traducerea a trei dintre cele mai spumoase povesti scrise de Joseph Jacobs. Traducerea este semnata de Cercul de Traduceri din cadrul proiectului Rose Mirages, al Facultatii de Litere si Stiinte ale Comunicarii, desfasurat la Universitatea Stefan cel Mare din Suceava.

Asociaţia „Artă şi Umanitate” a marcat 10 ani de activitate într-un cadru festiv
feeds.monitorulsv.ro - Suceava
Asociatia Arta si Umanitate a marcat joi, 13 decembrie, 10 ani de activitate intr-un cadru festiv, la Galeria de Arta Ion Irimescu Suceava, unde s-au adunat zeci de oameni care au dorit sa admire compozitiile expuse pe simeze, lucrari realizate de artisti plastici in perioada celor 10 ani de activitate 2008 - 2018 a asociatiei.

Tânărul care a descoperit „comoara vie” a identităţii noastre naţionale
feeds.monitorulsv.ro - Suceava
A fost odata ca niciodata, cand lumea asculta nemancata cate o poveste minunata, asa cum ascultam si noi azi. Si povestea, ca povestea, facuse coarne si iesea printre oameni si-i impungea, doar-doar c-o vor asculta...

Baby boom
feeds.monitorulsv.ro - Suceava
De o pre-vizionare a evenimentelor actuale din Franta am avut parte in 1968: n-oi fi chiar omul care aduce ploaie, dar am ghinionul sa nimeresc mereu acolo unde cad trasnetele! Cu un an inainte, in 1967, ma aflam la Atena, taman cand s-a petrecut violenta lovitura de stat prin care coloneii au preluat puterea, alungandu-l, in cele din urma, pe regele Constantin si instaurand dictatura militara.

Proiectul educativ „Vis de iarnă”, ediţia a III-a, la Centrul Școlar de Educaţie ...
feeds.monitorulsv.ro - Suceava
Elevii de la Centrul Scolar de Educatie Incluziva CSEI Sf. Andrei Gura Humorului au desfasurat recent proiectul educativ Vis de iarna, eveniment realizat la Centrul Cultural Gura Humorului. Aflat la a III-a editie, proiectul educativ Vis de iarna s-a desfasurat in mai multe etape. Mai intai, elevii indrumati de cadrele didactice au realizat un decor magic folosind pe cat posibil materiale reciclabile.

„Şi tu poţi fi Moş Crăciun”, ediţia a VI-a, la Câmpulung Moldovenesc
feeds.monitorulsv.ro - Suceava
La Clubul Aquarius Center din Campulung Moldovenesc va avea loc duminica, 16 decembrie, de la ora 14:00, actiunea umanitara Si tu poti fi Mos Craciun, editia a VI-a. Peste 50 de copii si tineri cu dizabilitati, insotitorii acestor copii si peste 100 de oameni care au ales sa fie Mos Craciun pentru unul din acesti copii si tineri cu nevoi speciale se vor afla duminica la Clubul Aquarius Center.

Noul stadion al echipei Dinamo va avea o capacitate de 20.000 de locuri
feeds.monitorulsv.ro - Suceava
Ministrul Afacerilor Interne, Carmen Dan, a declarat ca desi exista o intarziere in ceea ce priveste proiectul constructiei noului stadion de fotbal in cadrul Complexului Dinamo, din perspectiva institutiei pe care o conduce considera ca si-a atins obiectivul.

Multiplele accidentări le-au dat bătăi de cap universitarilor, în turul de campionat
feeds.monitorulsv.ro - Suceava
Echipa de handbal a Universitatii Suceava a incheiat in aceasta saptamana meciurile oficiale din Liga Nationala, pe anul 2018, si a intrat in vacanta pana la inceputul lunii viitoare. In cele 14 meciuri disputate, sucevenii au strans trei victorii, doua remize si noua infrangeri, si se afla pe locul 12, la un singur punct de locul 10.

Inter Conti va reprezenta Suceava la Cupa Unirii, de la Bucureşti
feeds.monitorulsv.ro - Suceava
Pentru al cincilea an consecutiv, angajati ai diverselor companii din Romania isi dau intalnire in Bucuresti in preajma Zilei Nationale a Romaniei pentru a participa in turneul de fotbal Cupa Unirii 2018.

Comuna Putna găzduieşte pentru al doilea an Cupa României la juniori I
feeds.monitorulsv.ro - Suceava
Sambata si duminica, sala de sport din comuna Putna va fi gazda Cupei Romaniei pentru juniori I la lupte greco-romane si lupte libere, o competitie ce se organizeaza in comuna suceveana pentru al doilea an consecutiv. In acest concurs vor intra pe saltea peste 400 de sportivi, ce vor reprezenta 38 de cluburi din tara la lupte greco-romane, lupte libere si lupte feminin.

Nu ştii ce să mai crezi
feeds.monitorulsv.ro - Suceava
Nu-mi aduc aminte ca fotbalul grecesc sa ma fi interesat vreodata, nici macar atunci cand am nimerit in preliminariile diverselor competitii la nivel de reprezentativa, nici in anii '70, nici in 2014. Iar cand Grecia a castigat Campionatul European, in 2004, zau ca am trecut intamplarea la capitolul anomalii inexplicabile.

LPS Suceava propune o serie de jucători talentaţi pentru echipele sucevene de Liga a III-a
feeds.monitorulsv.ro - Suceava
Dupa un tur de campionat in care a pierdut puncte importante din cauza greselilor de portar, Foresta poate lua in calcul ca exista chiar in oras o solutie viabila pentru intarirea acestui post. Jucatorul in cauza este Augustin Carbune, goal-keeper-ul grupei Under 19 de la Liceul cu Program Sportiv, clasata pe locul al doilea la finalul turului in Seria I a Campionatului National.

Găsiţi timp şi pentru Dumnezeu!
feeds.monitorulsv.ro - Suceava
Cand iti aduci aminte de Dumnezeu, inmulteste rugaciunea, ca atunci cand Il vei uita, Domnul sa-Si aduca aminte de tine. Deci, cand iti aduci aminte de Dumnezeu, ce sa faci? Inmulteste rugaciunea! De ce? Ca atunci cand Il vei uita, Domnul sa-Si aduca aminte de tine.

Sf. Ierarh Dosoftei, mitropolitul Moldovei, ocrotitorul spiritual al seminarului sucevean
feeds.monitorulsv.ro - Suceava
Elevii si cadrele didactice ale Seminarului Teologic Mitropolit Dosoftei Suceava l-au sarbatorit joi, 13 decembrie, pe Sf. Ierarh Dosoftei, mitropolitul Moldovei, ocrotitorul spiritual al seminarului. Sf Ier. Dosoftei a fost mitropolit al Moldovei si un important carturar si om duhovnicesc. S-a nascut intr-o familie credincioasa din Suceava, la botez primind numele de Dimitrie.

O femeie care mergea la serviciu, accidentată grav de o maşină în timp ce traversa strada
feeds.monitorulsv.ro - Suceava
O femeie in varsta de 51 de ani, din Ipotesti, a suferit leziuni foarte grave dupa ce a fost lovita violent de o masina in timp ce traversa strada, la iesirea din Ipotesti spre Suceava. Accidentul s-a petrecut vineri dimineata, in jurul orei 7.30, pe DJ 208A, iar momentul impactului a fost surprins de o camera de supraveghere. Clipele socantului accident pot fi vizionate pe site-ul cotidianului nostru.

Impactul unui autoturism cu un copac, fatal pentru o femeie
feeds.monitorulsv.ro - Suceava
O femeie in varsta de 57 de ani a murit intr-un accident rutier dupa ce masina in care se afla in calitate de pasagera a lovit un copac. Accidentul s-a petrecut joi, in jurul orei 11.30, pe DN 18, pe sectorul dintre limita cu judetul Maramures si localitatea suceveana Carlibaba. Accidentul in sine nu a fost unul violent, dar suficient pentru ca femeia care era pasagera pe bancheta din spate sa se loveasca la cap.

Doi tineri agresivi, care au produs scandal în faţa unui restaurant, au ajuns 24 de ore după ...
feeds.monitorulsv.ro - Suceava
O incaierare intre patru persoane, care a avut loc in timpul noptii de duminica spre luni in fata unui restaurant din comuna Vadu Moldovei, s-a soldat cu doi raniti si distrugerea unui autoturism apartinand uneia dintre victime. In urma cercetarilor efectuate de politisti, au fost identificati autorii, ei fiind doi tineri, ambii de 23 de ani, din comuna.

Prins la volan băut şi cu permisul suspendat, un bărbat a fost reţinut după gratii
feeds.monitorulsv.ro - Suceava
Un barbat s-a urcat la volan in timp ce avea permisul de conducere suspendat si apoi a refuzat sa-i fie prelevate probe biologice de sange, fapte ce i-au facut pe politisti sa ia masura retinerii sale dupa gratii pentru 24 de ore. Pentru comiterea celor doua infractiuni, el este cercetat in continuare sub control judiciar.

O ultimă condamnare în dosarul dealerilor de etnobotanice din reţeaua condusă de fraţii ...
feeds.monitorulsv.ro - Suceava
Tribunalul Suceava s-a pronuntat ieri si in cazul ultimei persoane anchetate in dosarul dealerilor de etnobotanice din reteaua condusa de fratii Ilie si Ioan Popovici. Trimis in judecata anul trecut, David Pastru, zis Haldan, a fost gasit vinovat pentru ambele infractiuni de care era acuzat.

15 Decembrie
feeds.monitorulsv.ro - Suceava
Batjocura sau ignoranta? Calatorind in timpul recent cu trenul care circuleaza de la Radauti la Brodina am aflat in cupeu, pe o hartia atarnata de parete, memorabila miserabila! inscriptiune: .

Peste 10.000 de pachete de ţigări şi un autoturism de teren, capturate la Vicovu de Sus
feeds.monitorulsv.ro - Suceava
Politistii de frontiera suceveni au interceptat, la mijlocul acestei saptamani, un transport ilegal de tigari de peste 25.000 de euro.

Reuniune transnaţională în Polonia la care au participat reprezentanţi ai Centrului Şcolar ...
feeds.monitorulsv.ro - Suceava
Centrul Scolar de Educatie Incluziva Suceava este beneficiarul unui proiect Erasmus intitulat Collaboration to Have Abilities as New Goals of Education CHANGE, ce se deruleaza in perioada 1 septembrie 2018 - 31 august 2020.

Două proiecte Erasmus+, la Colegiul „Mihai Eminescu” Suceava
feeds.monitorulsv.ro - Suceava
Inceputul acestui an scolar a coincis la Colegiul National Mihai Eminescu cu demararea a doua proiecte Erasmus, un program al Uniunii Europene care isi propune sa contribuie la dezvoltarea competentelor si capacitatii de insertie profesionala prin oferirea unor oportunitati de educatie, formare si activitati de tineret sau de sport, care se va desfasura pana in anul 2020.

Vernisajul expoziţiei “Târg boem la centenar”
feeds.monitorulsv.ro - Suceava
Miercuri, 12 decembrie, la Muzeul de Arta Ion Irimescu din Falticeni a avut loc vernisajul expozitiei Targ boem la centenar a artistul fotograf falticenean Codrin Anton.

Campanie de conştientizare a deficienţelor existente la infrastructura stradal-pietonală din ...
feeds.monitorulsv.ro - Suceava
Asociatia Help and Advice, in parteneriat cu Institutul pentru Parteneriat Social Bucovina, Centrul de Consiliere, Psihascend - Proiect Dizab-Tin-Act, Federatia Organizatiilor Neguvernamentale pentru Servicii Sociale FONSS, a initiat campania Suceava Accesibilizata, campanie de constientizare a deficientelor existente la infrastructura stradal-pietonala a municipiului Suceava din perspectiva adaptarii spatiului fizic.

Deputatul Dumitru Mihalescul şi liberalii rădăuţeni lansează campania caritabilă ...
feeds.monitorulsv.ro - Suceava
Deputatul PNL de Suceava Dumitru Mihalescul, impreuna cu organizatiile de seniori si tineret ale Partidului National Liberal din municipiul Radauti, lanseaza, la mijlocul saptamanii viitoare, campania caritabila Donathlon. Mai exact, liberalii radauteni fac apel catre cetatenii municipiului sa se prezinte miercuri, 19 decembrie 2018, incepand cu ora 08.00, la punctul de recoltare din cadrul Spitalului Municipal Sf.

Parada obiceiurilor de iarnă din municipiul Suceava va avea loc pe 27 decembrie
feeds.monitorulsv.ro - Suceava
Consiliul Judetean Suceava si Centrul Cultural Bucovina au anuntat programul evenimentelor culturale care au fost incluse in editia de anul acesta a proiectului Craciun in Bucovina. Manifestarile vor incepe duminica, 16 decembrie a.c., cu un spectacol de colinde sustinut de Ansamblul Artistic Ciprian Porumbescu pe esplanada Casei de Cultura din Suceava, care va avea loc intre orele 16:00 si 18:30.

Victimă salvată dintr-o maşină rămasă suspendată pe un pod, după ce a derapat pe gheaţă
feeds.monitorulsv.ro - Suceava
O femeie a fost salvata de pompieri dintr-o masina ramasa suspendata pe un pod din comuna Plopeni, dupa ce autoturismul a patinat pe drumul incarcat de gheata. Accidentul s-a produs in timpul zilei de joi, pe un drum comunal din localitatea Plopeni din comuna Salcea.

Cinci furnizori de servicii sociale din judeţul Suceava, premiaţi de Ministerul Muncii şi ...
feeds.monitorulsv.ro - Suceava
Cinci furnizori de servicii sociale din judetul Suceava au fost premiati recent de Ministerul Muncii si Justitiei Sociale.

„Noaptea cea mai lungă”, la Muzeul de Istorie
feeds.monitorulsv.ro - Suceava
Muzeul Bucovinei invita sucevenii, ca in fiecare an, sa sarbatoreasca impreuna Solstitiul de iarna - Noaptea cea mai lunga, la Muzeul de Istorie, sambata, 22 decembrie.

Deputatul USR Daniel Popescu a interpelat Ministerul Educaţiei în legătură cu situaţia ...
feeds.monitorulsv.ro - Suceava
Deputatul USR din Campulung Moldovenesc, Daniel Popescu, ales in Circumscriptia electorala nr.

Maricela Cobuz susţine un proiect de lege care vine în sprijinul medicilor rezidenţi
feeds.monitorulsv.ro - Suceava
Deputatul PSD de Suceava Maricela Cobuz a sustinut in Comisia pentru sanatate si familie din Camera Deputatilor o propunerea legislativa care vine in sprijinul medicilor rezidenti.

Cazuri noi de muncă nedeclarată
www.zi-de-zi.ro - Mureş
La nivelul Inspectoratului Teritorial de Muncă (ITM) Mureş, în cursul lunii noiembrie 2018, au fost

Florin BERCEAN este APĂRAT de sportivele sale. MESAJ tulburător postat de Larisa CONSTANTIN
evz.ro - Bucureşti
Florin Bercean, antrenorul lotului feminin de judo, este apărat şi de sportivele sale. Larisa Constantin, a reacţionat după scandalul creat de Gazeta Sportu...

Localnicii din Viseu de Sus sunt asteptati sa doneze sange
ziarmm.ro - Maramureş
Localnicii din Viseu de Sus, precum si cetatenii din localitatile limitrofe, sunt invitati sa daruiasca un strop de viata. Acestia sunt asteptati sa doneze sange marti, 18 decembrie a.c., la Laborator

Criminalul Sorin Rogia a fost condamnat la 23 ani şi 8 luni de detenţie, plus despăgubiri de 300.000 euro către părinţii victimei
www.ebihoreanul.ro - Bihor
Sorin Rogia, autorul sângeroasei crime căreia i-a căzut victimă orădeanul Radu Bogdan, un tânăr de 27 de ani găsit cu capul zdrobit în zorii zilei de 9 noiembrie anul trecut, a fost condamnat, vineri, la 23 ani şi 8 luni de detenţie, plus despăgubiri morale de 300.000 euro către părinţii victimei sale.

FOTO Sibiul sub cod galben de ninsoare. Cum se circulă în judeţ
info.oradesibiu.ro - Sibiu
În judeţul Sibiu a nins câteva ore bună în noaptea de vineri spre sâmbătă. Pe drumurile naţionale care străbat judeţul Sibiu drumarii au ieşit cu autospeciale de deszăpezire şi au împrăştiat material antiderapant. La această oră se circulă bine, dar în condiţii de iarnă. Sâmbătă dimineaţa pe DN 7C km…

ZILE LIBERE 2019. Cumulat, anul viitor, români vor sta acasă două săptămâni
ziarulunirea.ro - Alba
Doritorii se pot ocupa deja de planurile pentru minivacanţele de anul viitor. În 2019, românii vor avea 15 zile libere. Înainte de sfârşitul anului, ne mai aşteaptă 4 zile libere: 24, 25, 26 şi 31 decembrie. 2019 va începe cu două zile libere: 1 şi 2 ianuarie. În luna ianuarie, ziua de 24 este liberă, …

Kosovo îşi face armată. ONU discută în timp ce Serbia şi Rusia se opun
evz.ro - Bucureşti
Decizia Parlamentului de la Pristina, Kosovo, de a înfiinţa o armată de 5.000 de militari, pentru protecţia provinciei, a dus la o întâlnire informală a Con...

Agenda parlamentară: Lupescu (USR) rămâne prietenul copiilor de la “Smaranda Gheorghiu”
www.gazetadambovitei.ro - Dâmboviţa
Deputatul USR Dâmboviţa, Dumitru Lupescu a revenit la copiii de la Școala multietnică “Smaranda Gheorghiu” din Târgovişte, pentru a-i premia

OREZ CONTAMINAT. 11 morţi, alertă de sănătate publică. UNDE AU FOST raportate PRIMELE CAZURI
evz.ro - Bucureşti
Unsprezece persoane au murit după ce au consumat orez, contaminat probabil cu o substanţă toxică, la o ceremonie organizată într-un templu hindus din oraşul...

PMP solicită parlamentarilor puterii să voteze moţiunea de cenzură împotriva Guvernului Dăncilă
www.gazetadambovitei.ro - Dâmboviţa
Secretarul general adjunct al Partidului Mişcarea Populară (PMP), Ioana Constantin a participat vineri, 14 decembrie, alături de preşedintele PMP Dâmboviţa,

Accident rutier pe DN 23. Implicate doua autoturisme. O victima. Trafic intrerupt
www.ziuaconstanta.ro - Constanţa
Centrul INFOTRAFIC din Inspectoratul General al Politiei Romane informeaza ca circulatia rutiera este intrerupta pe DN 23 Braila Focsani, la intersectia cu DJ 221C, in afara localitatii Silistea, ...

Isărescu şochează! Ce vor americanii de la România
evz.ro - Bucureşti
Isărescu şochează! Ce vor americanii de la România...

Captivi în ministere. Stănescu şi Șova ar putea fi menţinuţi în funcţie până când vrea preşedintele. Doar CCR îi poate elibera
evz.ro - Bucureşti
Preşedintele Klaus Iohannis a trimis, în termen, Curţii Constituţionale punctul său de vedere referitor la sesizarea făcută de premierul Viorica Dăncilă, în...

Urmărit internaţional prins la Satu Mare. A agresat o persoană!
portalsm.ro - Satu Mare
Urmărit internaţional prins la Satu Mare. A agresat o persoană!

Cantitate uriasa de droguri, distrusa de politie
www.ziuaconstanta.ro - Constanţa
Politia Romana, cu sprijinul unui operator autorizat, a distrus 4.000 de kilograme de droguri de risc si de mare risc, substante stupefiante confiscate in dosare penale din ultimii ani. In perioada 13 - ...

A FOST RÂNDUL TIR-ULUI SĂ „RUPĂ” AUTOSTRADA
ziarulargesul.ro - Argeş
După accidentul spectaculos de ieri, în această dimineaţă, din pricina carosabilului alunecos, un şofer de TIR a derapat şi a distrus glisiera de pe Autostrada A1, la km. 106 (sensul către Bucureşti). Nimeni nu a fost rănit, iar traficul a fost blocat pe o singură bandă. Poliţia Argeş recomandă...

Inima Reginei – expoziţie de artă vizuală la Casa Junilor
feedproxy.google.com - Braşov
Asociaţia Culturală Artessentia vă invită să participaţi la vernisajul expoziţiei de artă vizuală “INIMA REGINEI” care va avea loc la Casa Junilor (parter), str. Prundului nr. 1, Braşov, sâmbătă, 15 decembrie, orele 17.00. „Expoziţia este intenţia şi maniera noastră de a onora memoria Reginei României Mari. Prin testamentul adresat Poporului şi Ţării sale, Regina Maria

Cod Portocaliu în zona montană. NU plecaţi la drum neechipaţi corespunzător!
www.gazetadambovitei.ro - Dâmboviţa
Peisaje de poveste în munte, dar fără o echipare corespunzătoare a maşinilor poate deveni un coşmar. Zona montantă este în

Cum au revoluţionat transportul aerian despăgubirile de întârziere zboruri
evz.ro - Bucureşti
Este important deci să fiţi conştienţi de aceste beneficii pe care le meritaţi şi să le solicitaţi aşa cum se cuvine. Din păcate există foarte multe obstaco...

Dezastru socio-economic? CIFRE NEGRE pentru milioane de români. Breaking news
evz.ro - Bucureşti
Datoria totală a populaţiei faţă de bănci a continuat să se majoreze într-un ritm susţinut, crescând cu 8,3 la sută, până la valoarea de 147 miliarde lei (3...

FOTO/VIDEO. Ninge la Satu Mare! Cum va fi vremea în weekend
portalsm.ro - Satu Mare
Iarna şi-a făcut simţită prezenţă în această dimineaţă, la Satu Mare. Primii fulgi de zăpadă au apărut încă de la primele ore ale dimineţii, iar stratul alb

FOTO/VIDEO. Ninge la Satu Mare! Cum va fi vremea în weekend
portalsm.ro - Satu Mare
Iarna şi-a făcut simţită prezenţă în această dimineaţă, la Satu Mare. Primii fulgi de zăpadă au apărut încă de la primele ore ale dimineţii, iar stratul alb

Veştea a semnat rezoluţia PNL pentru infrastructura din Centrul ţării
feedproxy.google.com - Braşov
PNL a organizat la Alba Iulia o întâlnire a liderilor din cele şase judeţe ale Regiunii de dezvoltare Centru, care au adoptat o rezoluţie privind dezvoltarea zonei. Cei şase lideri, Mircea Hava (Alba), Raluca Turcan (Sibiu), Cristian Chirteş (Mureş), Stelian Olumpiu Floroian (Covasna), Adrian – Ioan Veştea (Braşov) şi Sebastian Victor Buzilă (Harghita) au discutat,

FOTO. Primii fulgi de nea au transformat Timişoara într-un oraş de poveste!
expressdebanat.ro - Caraş-Severin
A nins ca în poveşti vineri seară, la Timişoara. Oraşul de pe Bega s-a îmbrăcat în alb în doar câteva ore, iar timişorenii care au ieşit la plimbare au avut parte de peisaje de poveste.

Tarom a pus în vânzare biletele de la Oradea spre Milano şi Barcelona. Află preţurile!
www.ebihoreanul.ro - Bihor
Compania Tarom a pus în vânzare, începând de sâmbătă, bilete pentru cursele Oradea - Milano (Bergamo) şi Oradea - Barcelona, care vor fi operate din primăvara anului viitor. Biletele pot fi cumpărate din agenţiile Tarom.

FEMEI CONTRABANDISTE SUB CONTROL JUDICIAR
ziarulargesul.ro - Argeş
Fiindcă deţineau şi comercializau ţigări şi petarde fără drept, trei suspecţi au fost ridicaţi şi duşi la sediul Poliţiei Costeşti pentru audieri şi trei dintre ei au fost reţinuţi pe bază de ordonanţă şi încarceraţi în arestul poliţiei argeşene. Aceştia sunt Ion I., de 39 de ani, Anda N., de 28...

Românii sunt SCLAVII BĂNCILOR! Cât de îndatoraţi suntem. Suma este AMEȚITOARE
evz.ro - Bucureşti
Datoria totală a populaţiei faţă de bănci a continuat să se majoreze într-un ritm susţinut, crescând cu 8,3 la sută, până la valoarea de 147 miliarde lei (3...

Probleme mari pentru Viorica Dîăncilă. Ce a păţit la Bruxelles
evz.ro - Bucureşti
Probleme mari pentru Viorica Dîăncilă. Ce a păţit la Bruxelles...

MOMENTE GRELE pentru Andra. Tot showbizul aşteaptă REACŢIA LUI MĂRUŢĂ. A fost o veste dură pentru artistă...
evz.ro - Bucureşti
Vineri seară a avut loc finala Vocea României de la Pro Tv. Câştigătorul concursului a fost concurentul Bogdan Ioan, din echipa lui Smiley. La rândul ei, An...

Daruri în prag de sărbători pentru elevii din cadrul proiectului „O şansă pentru comunităţile marginalizate din Caransebeş“
expressdebanat.ro - Caraş-Severin
Peste 130 de elevi din Caransebeş au fost vizitaţi de primarul Felix Borcean, care s-a gândit ca în prag de sărbători şi aceşti elevi, proveniţi din familii defavorizate, să se bucure de un mic dar oferit cu toată căldura de angajaţii Biroului de Proiecte şi Programe din cadrul Primăriei.

Bara Sulina a fost inchisa din cauza vantului puternic
www.ziuaconstanta.ro - Constanţa
Centrul INFOTRAFIC din Inspectoratul General al Politiei Romane informeaza ca, incepand cu ora 09 00, Bara Sulina a fost inchisa. Cauza inchiderii este vantul puternic. ...

Cine curăţă zăpada? Comandamentul de Iarnă din Lugoj caută firmă de deszăpezire
expressdebanat.ro - Caraş-Severin
Intrarea în insolvenţă a societăţii Salprest, cea care în anii trecuţi s-a ocupat de curăţirea de zăpadă a oraşului, dă mari bătăi de cap administraţiei locale lugojene.

Iulia Vântur, DEVASTATĂ! Lacrimi amare... Salman Kahn a ÎNCHEIAT-O cu o singură MUTARE
evz.ro - Bucureşti
Relaţia dintre Salman Kahn şi Iulia Vântur a început să scârţâie. Indianul a ales să vină cu o altă femeie la cea mai fastuoasă nuntă din India. ...

SHAKIRA, acuzată de FRAUDĂ FISCALĂ. Cât DATOREAZĂ vedeta statului spaniol
evz.ro - Bucureşti
Shakira a fost pusă sub acuzare pentru fraudă fiscală în Spania. Procuratura din Madrid informează că starul muzicii internaţionale datorează statului peste...

Augustin face pasul înapoi. Puţini credeau că TAICA LAZĂR VA CEDA. News alert în Justiţie
evz.ro - Bucureşti
Avocaţii au reclamat, inclusiv în Comisia pentru cercetarea abuzurilor, combaterea corupţiei şi petiţii din Senat, că se simt umiliţi când li se iau telefoa...

FOTO: Ninsorile din ultimele ore au produs efecte în şapte judeţe
www.gorjeanul.ro - Gorj
La nivel naţional, în ultimele 24 de ore au fost ninsori, lapoviţă, ploi şi polei, în cea mai mare parte a ţării. Meteorologii au emis Cod Portocaliu de nisori abundente, strat semnidicativ de zăpadă şi viscol în nouă judeţe ale ţării: Argeş, Caraş-Severin, Dâmboviţa, Gorj, Huned

Politia Romana: Noi masuri preventive ce stabilesc supravegherea judiciara, pentru 113 persoane
www.ziuaconstanta.ro - Constanţa
In ultima saptamana, la nivel national, a fost dispusa masura arestului la domiciliu fata de 31 depersoane si cea a controlului judiciar fata de alte 82 de persoane. Politia Romana verifica, ...

FOTO, VIDEO: Poveste de iarnă la Alba Iulia. Imagini dintr-o lume ireal de frumoasă din Cetatea Alba Carolina, după ninsoare
ziarulunirea.ro - Alba
A nins ca în poveşti la Alba Iulia. Zăpada a luat oraşul în stăpânire şi l-a transformat într-o lume ireal de frumoasă. Ramurile copacilor par acum candelabre uriaşe din cristal. Clădirile din Cetatea Alba Carolina sunt decorate cu draperii de ţurţuri, care parcă plutesc. Iarna a transformat oraşul într-un tărâm de poveste. Pe băncile din …

Final de campanie împotriva violenţei în familie
www.zi-de-zi.ro - Mureş
Acţiunea numită „16 zile de activism împotriva violenţei în familie” s-a desfăşurat în perioada 25

Tenis: Arena Wimbledon isi va mari suprafata prin achizitionarea terenului de golf din vecinatate
ziarmm.ro - Maramureş
Proiectul privind extinderea arenei de tenis de la Wimbledon a facut un pas inainte joi, dupa ce membrii unui club local de golf aflat in vecinatate au votat vanzarea terenului lor catre organizatorii

Premiul WTA pentru lovitura anului, castigat de Simona Halep
www.ziuaconstanta.ro - Constanţa
Simona Halep a castigat concursul pentru lovitura anului, in ancheta efectuata de WTA, pentru cea din meciul din luna martie cu Agnieszka Radwanska, din turul al treilea al Miami Open, scrie Romania TV. ...

Au scăpat de umilinţă. Au dreptul să folosească telefonul
evz.ro - Bucureşti
Avocaţii au reclamat, inclusiv în Comisia pentru cercetarea abuzurilor, combaterea corupţiei şi petiţii din Senat, că se simt umiliţi când li se iau telefoa...

A scăpat ca prin MINUNE. La un pas de a fi RĂPITĂ din plină stradă de un BĂRBAT
evz.ro - Bucureşti
Margareta Kovacs o femeie la locul ei, cu o relaţie stabilă de ceva timp, a avut parte de o adevărată încercare e vieţii, după ce a fost acostată într-un au...

Zeci de animale vor fi sacrificate la Șelaru. Autorităţile supraveghează ferma de porci şi vor institui filtre
www.gazetadambovitei.ro - Dâmboviţa
Comunicat de presă Institutul de Diagnostic şi Sănătate Animală Bucureşti a confirmat apariţia virusului de pestă porcină africană în

De ce e important să le citim copiilor când sunt mici
www.oradesibiu.ro - Sibiu
Este cunoscut faptul că cititul, atunci când suntem mici, ne dezvoltă imaginaţia, capacitatea de concentrare, dar şi creativitatea. Până când copiii vor creşte şi vor descoperi singuri magia lecturii însă, este bine ca părinţii să le citească seară de seară. Cititul încurajează setea de cunoaştere În cărţi există numeroase informaţii…

Pompier român, locul 2 la un maraton de la Polul Sud – A alergat pentru copiii cu autism
www.oradesibiu.ro - Sibiu
Un pompier din Botoşani a reuşit să se claseze pe locul al doilea, la un maraton de la Polul Sud. Iulian Rotariu a parcurs 250 de kilometri, într-o perioadă de două săptămâni, la temperaturi de aproximativ -60 de grade Celsius. Pompierul român a parcurs etapele ultramaratonului „The Last Desert” şi…

VIDEO Record mondial – O bătrânică de 102 ani a sărit cu paraşuta
www.oradesibiu.ro - Sibiu
O bătrânică curajoasă, în vârstă de 102 ani, a stabilit un record la nivel mondial: a devenit cea mai vârstnică persoană care a sărit cu paraşuta. Irene O'Shea a sărit de la o altitudine de 4.267 de metri, deasupra sudului Australiei cu ajutorul unui instructor de paraşutism. Ea a fost…

STUDIU: Broaştele care trăiesc în oraş scot sunete mai atractive decât cele de la sat
www.oradesibiu.ro - Sibiu
Potrivit unui studiu, broaştele tungana, cele care trăiesc în zonele urbane, emit sunete de împerechere mult mai atractive decât celelalte broaşte care trăiesc în păduri sau în mediul rural. Specialiştii spun că sunetele sunt mult mai complexe. Conform Atlas Obscura, citat de descopera.ro, mare parte din broaştele tungara observate în…

FOTO Accident pe Vasile Milea. A trecut pe roşu
www.oradesibiu.ro - Sibiu
Sâmbătă dimineaţa un şofer neatent a provocat un accident de circulaţie pe bulevardul Vasile Milea. Șoferul, de 41 de ani din Șelimbăr, venea către centrul Sibiului. La intersecţie cu strada Nicolae Iorga nu a oprit la culoarea roşie a semaforului şi a intrat în coliziune cu un autoturism condus regulamentar.…

CSU Sibiu joacă sâmbătă cu SCM U Craiova – Anunţ important pentru suporteri
info.oradesibiu.ro - Sibiu
Baschetbaliştii sibieni joacă sâmbătă, de la orele 18:00, pe teren propriu, în compania celor de la SCM Craiova, lideri ai clasamentului Ligii Naţionale de Baschet Masculin. Fanii echipei sunt rugaţi să vină la meci cu un cadou într-o cutie de pantofi, sau mai scurt, cu un ShoeBox. Ultimele bilete disponibile…

Zeci de animale vor fi sacrificate la Șelaru. Se. vor institui filtre. Autorităţile supraveghează fermă în care a fost confirmat focarul
www.gazetadambovitei.ro - Dâmboviţa
Comunicat de presă Institutul de Diagnostic şi Sănătate Animală Bucureşti a confirmat apariţia virusului de pestă porcină africană în

Ierusalimul de Vest, capitala Israelului. ÎNCĂ UN PAS a fost făcut recent. Breaking news
evz.ro - Bucureşti
După Statele Unite ale Americii, un alt stat important recunoaşte Ierusalimul de Vest, drept capitală a Israelului. aaaaaaaaaaa...

Detalii neştiute despre câştigătorul de la Vocea României! Ce a studiat Bogdan Ioan şi cum câştigă bani
evz.ro - Bucureşti
Bogdan Ioan este marele căştigător de la Vocea României. El a făcut senzaţie pe scena de la Vocea României încă de la prima sa apariţie....

Piatra-Neamţ: Gavrilescu (PMP) propune mărirea preţului la parcări, PNL va vota împotrivă
www.stiri-neamt.ro - Neamţ
Consilierii locali din Piatra-Neamţ vor avea de votat marţi, 18 decembrie, un proiect de hotărâre iniţiat de viceprimarul PMP, Bogdan Gavrilescu, la

Minaur Baia Mare are nevoie, astazi, de sustinerea suporterilor! Echipa se afla la 60 de minute de Final Four-ul Cupei Romaniei Fan Courier
ziarmm.ro - Maramureş
Minaur Baia Mare se afla la un pas de Final Four-ul Cupei Romaniei Fan Courier la Handbal Masculin. Pentru a accede in careul de asi, baimarenii mai trebuie sa treaca de SCM Politehnica Timisoara. Par

DN 71 – Două persoane rănite în coliziunea dintre două maşini
www.gazetadambovitei.ro - Dâmboviţa
Condiţiile meteo pun probleme şoferilor din judeţ. Ninge viscolit şi este foarte greu de păstrat carosabilul curat. În aceste condiţii,

Australia face un anunţ important!!! Este pregătită să recunoască capitala ...
evz.ro - Bucureşti
După Statele Unite ale Americii, un alt stat important recunoaşte Ierusalimul de Vest, drept capitală a Israelului....

Evenimente INCENDIARE la Alba Iulia. S-a ales NOUL PREMIER al României. „Eu sunt!”
evz.ro - Bucureşti
Liderul liberalilor Ludovic Orban, aflat la Alba Iulia, alături de Raluca Turcan şi Mircea Hava, au fost prezenţi la o întâlnire a reprezentanţilor PNL din ...

Maramures: Drumarii au imprastiat 48 de tone de sare. Vezi aici, care este starea soselelor
ziarmm.ro - Maramureş
Carosabilul sectoarelor de drumuri nationale din judet se prezinta astfel: pe DN 18B, DN 1C si E58 soseaua este uscata, pe DN 18 drumul este umed, mai exact pe raza localitatii Baia Sprie, dar si in P

ATENŢIE la drumuri! Pe Arad – Timişoara e ZĂPADĂ, la fel şi pe multe alte drumuri. PERICOL pe AUTOSTRADĂ! Primele ACCIDENTE (FOTO)
newsar.ro - Arad
Citeşte azi ce scriu ziarele de mâine!

PERICOL uriaş pentru BEBELUŞI. Adevărul a fost AFLAT
evz.ro - Bucureşti
Compania americană Johnson & Johnson cunoştea de mai bine de câteva decenii că în pudra pentru copii pe care o produce există azbest. Această substanţă toxi...

Au apărut brazii în pieţele orădene
www.ebihoreanul.ro - Bihor
Primii brazi de Crăciun au ajuns în aceste zile în pieţele orădene. Oferta este bogată, iar preţurile sunt apropiate de cele practicate anul trecut, începând de la 20 lei şi ajungând până la 100 lei sau chiar mai mult, în funcţie de înălţimea, provenienţa şi coroana bradului.

SCANDAL cu România TV în prim-plan. PRO TV, ATACATĂ de un DOCTOR ÎN MEDIA: „Dezbateri reale şi credibile, la un nivel fără egal”
evz.ro - Bucureşti
Ediţia recent încheiată a Premiilor Naţionale de Televiziune APTR (respectiv premiile Asociaţiei Profesioniştilor de Televiziune din România) l-a făcut pe u...

ATENŢIE la drumuri! Pe Arad – Timişoara e ZĂPADĂ, la fel şi pe multe alte drumuri (FOTO)
newsar.ro - Arad
Citeşte azi ce scriu ziarele de mâine!

Sărbătorile de iarnă se scriu în condica eleganţei, bunului gust şi rafinamentului
expressdebanat.ro - Caraş-Severin
Staţiunea de pe Valea Cernei străluceşte în această iarnă, sub lumina reflectoarelor marelui Hotel Minerva, una dintre perlele zonei.

Pensii Neamţ: Informare despre contractele de asigurare socială
www.stiri-neamt.ro - Neamţ
Potrivit dispoziţiilor HG nr.937/2018 pentru stabilirea salariului de bază minim brut pe ţară garantat în plată, începând cu data de 01 ianuarie 2019,

Lidia Buble şochează! Câţi bani datorează Fiscului şi de ce nu vrea să-şi plătească datoriile
evz.ro - Bucureşti
Lidia Buble este una dintre cel mai bine plătite cânăreţe din România. Notorietatea acesteia a crescut serios odată cu relaţia ei cu matinalul de la Antena ...

Gaze contra apă. Două ţări europene fac o mişcare strategică în domeniul energetic. România ar putea fi scoasă din joc
evz.ro - Bucureşti
Un acord bilateral în domeniul energetic, încheiat vineri între Ungaria şi Cipru, pune mari semne de întrebare în legătură cu acţiunile viitoare ale guvernu...

Vocea României. Câţi se aşteptau la VESTEA CARE DEREGLAT RATINGUL? PRO TV arată de ce domină televiziunea din România
evz.ro - Bucureşti
Marele trofeu Vocea României şi premiul în valoare de 100.000 de euro, a fost câştigat de Bogdan Ioan. Cei patru concurenţi calificaţi în finală au demonstr...

Volei: Astazi este ultimul meci din 2018 pentru Stiinta Explorari. Partida se disputa in Sala Sporturilor “Lascar Pana”
ziarmm.ro - Maramureş
Astazi, de la ora 12.00, Stiinta Explorari va juca, in Sala “Lascar Pana”, ultimul meci din acest an. Echipa baimareana va intalni SCMU Craiova, iar partida face parte din etapa a 11-a, ultima din tur

Prima zăpadă, prima INTERVENŢIE a utilajelor de deszăpezire în municipiu. Şi REALITATEA
newsar.ro - Arad
Citeşte azi ce scriu ziarele de mâine!

Accident la Bâlteni
www.gorjeanul.ro - Gorj

Focar de pesta porcină, confirmat în sudul jdeţului, cu câteva zile înainte de Crăciun
www.gazetadambovitei.ro - Dâmboviţa
Autorităţile confirmă apariţia unui focar de pesta porcină în sudul judeţului, la Șelaru. Focarul a fost confirmat într-o fermă locală

Didactica. Fonetică şi fonologie
www.zi-de-zi.ro - Mureş
Termenii folosiţi, „fonetic” şi „fonologie”, ar fi într-un raport care presupune noţiunile de partic

Mos Craciun a trecut deja prin localitatea Tautii Magheraus
ziarmm.ro - Maramureş
Piticii de la gradinita Liceului “Traian Vuia”, din Tautii Magheraus, coordonati de educatoarea Cosmina Canta, au oferit parintilor un spectacol deosebit. Acestia au cantat, au spus poezii si au dansa

Lansare de carte: “Bistriţa-Năsăud. Generaţia Marii Uniri”, volumul 2
www.timponline.ro - Bistriţa-Năsăud
Asociaţia Profesorilor de Istorie din România-filiala Bistriţa-Năsăud (APIR BN) organizează marţi 18 decembrie, ora 16.00, în sala de consiliu a Palatului Administrativ, lansarea celui de-al doilea volum al cărţii “Bistriţa-Năsăud. Generaţia Marii Uniri”.
Lucrarea cuprinde studii şi cercetări de

RĂZBOI TOTAL la graniţă! TRUPELE MILITARE, mobilizate. România şi NATO au reacţionat IMEDIAT
evz.ro - Bucureşti
O intervenţie militară sârbă în Kosovo este foarte posibilă, după decizia Parlamentului de la Priştina de a forma o armată, a anunţat un consilier prezidenţ...

FOTO Accident pe Vasile Milea. A trecut pe roşu
info.oradesibiu.ro - Sibiu
Sâmbătă dimineaţa un şofer neatent a provocat un accident de circulaţie pe bulevardul Vasile Milea. Șoferul, de 41 de ani din Șelimbăr, venea către centrul Sibiului. La intersecţie cu strada Nicolae Iorga nu a oprit la culoarea roşie a semaforului şi a intrat în coliziune cu un autoturism condus regulamentar.…

Patru ani de la tragedia de pe lacul Siutghiol. Patru salvatori SMURD au murit
www.ziuaconstanta.ro - Constanţa
Astazi se implinesc patru ani de la accidentul aviatic din zona lacului Siutghiol, in care si-au pierdut viata membrii echipajului elicopterului SMURD pilotul cmdr. Petre Corneliu Catuneanu, copilotul cpt. ...

Meteo. Fenomen rar din cauza frigului extrem. S-a ajuns şi la AccuWeather. Foto în articol
evz.ro - Bucureşti
Un fenomen meteo extrem de rar, cunoscut sub denumirea de stâlpi de lumină, a avut loc pe cerul localităţii Bloit din statul american Wisconsin. ...

Ședinţă a Consiliului Judeţean în 19 decembrie
www.timponline.ro - Bistriţa-Năsăud
Consiliul Judeţean Bistriţa-Năsăud este convocat în şedinţă ordinară miercuri 19 decembrie, ora 12.00, în sala de şedinţe a Palatului Administrativ. Ordinea de zi:

Meteo: Vremea este inchisa si astazi. Temporar va ninge. Temperaturi de -5 grade C la Borsa si Cavnic
ziarmm.ro - Maramureş
Vremea a fost apropiata de normalul termic al perioadei. Cerul a fost temporar noros. Vantul a suflat slab la moderat. Temperatura maxima a fost cuprinsa intre 0 grade la Ocna Sugatag si 4 grade C in

Prezidii cu gogoşi, aranjamente florale cu mere verzi, dreamcatcher şi cheesebar cu jumări! Ultimele tendinţe pentru nunţi, la Timişoara Wedding Market
expressdebanat.ro - Caraş-Severin
Cei care doresc să îşi unească destinele se pot inspira weekendul acesta la Timişoara Wedding Market, târg de nunţi cu oferte pe toate gusturile. De la servicii foto-video, la prăjituri, săli, decoruri florale şi nu numai, verighete, rochii de mirese, costume de miri, invitaţii şi chiar contractarea unui wedding planner, ca în celebrul film cu acelaşi nume şi cu Jennifer Lopez în rolul principal. Vizitatorii pot găsi aproape tot ce le pofteşte inima şi le poate visa imaginaţia.

Meteo. Starea drumurilor sub viscol. Ce drumuri sunt închise.
evz.ro - Bucureşti
Meteo şi INFOTRAFIC. Ce drumuri sunt închise la ora 7:00 în România, după instalarea Codului Portocaliu. Ameninţarea viscolului....

Meteo. Fenomen rar din cauza frigului extrem. Reacţia celor de la AccuWeather. Foto în articol
evz.ro - Bucureşti
Un fenomen meteo extrem de rar, cunoscut sub denumirea de stâlpi de lumină, a avut loc pe cerul localităţii Bloit din statul american Wisconsin. ...

STUDIU: Broaştele care trăiesc în oraş scot sunete mai atractive decât cele de la sat
info.oradesibiu.ro - Sibiu
Potrivit unui studiu, broaştele tungana, cele care trăiesc în zonele urbane, emit sunete de împerechere mult mai atractive decât celelalte broaşte care trăiesc în păduri sau în mediul rural. Specialiştii spun că sunetele sunt mult mai complexe. Conform Atlas Obscura, citat de descopera.ro, mare parte din broaştele tungara observate în…

VIDEO Record mondial – O bătrânică de 102 ani a sărit cu paraşuta
info.oradesibiu.ro - Sibiu
O bătrânică curajoasă, în vârstă de 102 ani, a stabilit un record la nivel mondial: a devenit cea mai vârstnică persoană care a sărit cu paraşuta. Irene O'Shea a sărit de la o altitudine de 4.267 de metri, deasupra sudului Australiei cu ajutorul unui instructor de paraşutism. Ea a fost…

Un grup de GENERALI FRANCEZI îl ACUZĂ pe MACRON DE TRĂDARE. „Alegerea dvs. ca preşedinte nu este un cec în alb.”
evz.ro - Bucureşti
De ce nu s-a dus Emmanuel Macron la Marrakech să semneze Pactul ONU privind imigraţia, pact pe care îl susţine? Cei mai mulţi comentatori pun decizia preşed...

Peste 500 de păsări şi animale mici de rasă, în competiţie la Caransebeş. În acest weekend!
expressdebanat.ro - Caraş-Severin
Sala Polivalentă din Caransebeş găzduieşte în premieră, până duminică, 16 decembrie, o nouă ediţie a Expoziţiei Anuale Judeţene de Păsări de Curte, Păsări Ornamentale, Porumbei, Iepuri şi Păsări Exotice.

Slujbaşi versus oameni liberi
www.timponline.ro - Bistriţa-Năsăud
Am auzit de atâtea ori povestea bietului angajat la stat - slujbaşul - terorizat de "publicul" veşnic nemulţumit încât simt nevoia să spun câteva lucruri, mai ales că am fost invitată să mă alătur măcar pentru o zi funcţionarilor şi să văd dacă pe mine mă ajută mai mult nervii când contribuabilii vi

Trafic rutier, blocat la Ciuperceni din cauza unui tir care a derapat
www.gorjeanul.ro - Gorj

Piatra-Neamţ: Târgul de Crăciun – Programul zilei de sâmbătă, 15 decembrie 2018
www.stiri-neamt.ro - Neamţ
Al doilea final de săptămână la Târgul de Crăciun la Neamţ, ediţia anului 2018, aduce noi artişti pe scena amplasată pe Platoul Curţii Domneşti. Astfel,

VIDEO ŞOCANT! Şofer din Alba, şicanat în trafic de maşina din spate, la un pas să spulbere doi pietoni, pe o trecere, în Cluj
ziarulunirea.ro - Alba
Un şofer cu un autoturism înmatriculat în Alba a fost la un pas să spulbere doi pietoni de pe o trecere, vineri seara, în municipiul Cluj Napoca. Scena a fost surprinsă de un alt participant la trafic. În imagini se vede cum un autoturism cu numere de Alba trece este la un pas să lovească …

BREXIT. Theresa MAY, încercare DISPERATĂ de a SALVA ce se mai poate
evz.ro - Bucureşti
Theresa May a declarat vineri că vor avea loc noi discuţii cu Uniunea Europeană în următoarele zile pentru a obţine mai multe garanţii asupra acordului priv...

Povestea unui CĂLĂU care şi-a mâncat VICTIMA. Reporter de Cursă Lungă
evz.ro - Bucureşti
De dimineaţă a decapitat-o cu sânge rece şi, câteva ore mai târziu, a mâncat-o, pofticios, cu pilaf. Acu’ fo treijdoi de ani, într-o dimineaţă, pe strada...

Teohari Georgescu, turnat la Scânteia şi acuzat că şi-a deschiaburit neamurile
evz.ro - Bucureşti
Materialele pe care se bazează articolele de mai jos au fost produse de la ziarul Scânteia, organul de presă al PCR, şi Secţia Cadre, parte a aparatului CC ...

IPJ Neamţ: Sfaturi pentru cumpărături în siguranţă
www.stiri-neamt.ro - Neamţ
Inspectoratul de Poliţie al judeţului Neamţ derulează în perioada 03-31 decembrie a.c. campania de informare pentru prevenirea infracţiunilor specifice

Pompier român, locul 2 la un maraton de la Polul Sud – A alergat pentru copiii cu autism
info.oradesibiu.ro - Sibiu
Un pompier din Botoşani a reuşit să se claseze pe locul al doilea, la un maraton de la Polul Sud. Iulian Rotariu a parcurs 250 de kilometri, într-o perioadă de două săptămâni, la temperaturi de aproximativ -60 de grade Celsius. Pompierul român a parcurs etapele ultramaratonului „The Last Desert” şi…

În Reşiţa se circulă… la minut! Călătorii găsesc graficul de transport online
expressdebanat.ro - Caraş-Severin
Până când proiectul cu reintroducerea tramvaiului devine realitate, iar fiecare staţie va avea amplasat afişaj electronic pentru a informa călătorii cât mai au de aşteptat, societatea Transport Urban Reşiţa a postat graficul de circulaţie online. La minut!

Cine să-i mai înţeleagă… Aquacaraşul – pe marginea prăpastiei sau pe drumul spre izbândă?
expressdebanat.ro - Caraş-Severin
Încurcate sunt căile apei în societatea Aquacaraş... Atât de încurcate, încât până şi şefii judeţului văd situaţia diferit. Dacă Ionuţ Popovici a mers până într-acolo încât să îi ceară public demisia directorului Ciobanu, celălalt vicepreşedinte, Flavius Nedelcea, vede o apă mult mai... cristalină.

Screeningul pentru neuropatie diabetica este obligatoriu in lupta cu aceasta afectiune
ziarmm.ro - Maramureş
Screeningul pentru neuropatie diabetica este obligatoriu in lupta cu aceasta afectiune, subliniaza specialistii in domeniu, potrivit Agerpres. "Lupta impotriva diabetului zaharat presupune o abordare

Amplasarea radarelor în weekendul 15-17 decembrie 2018, în judeţul Alba. Care sunt drumurile monitorizate de Poliţie
ziarulunirea.ro - Alba
Inspectoratul de Poliţie Judeţean (IPJ) Alba face publică amplasarea radarelor din judeţul Alba, în perioada 15-17 decembrie 2018. Îm weekend, poliţiştii vor fi la datorie, pentru sancţionarea persoanelor care depăşesc viteza legală, pe drumurile naţionale, judeţene şi din municipii. Amplasarea radarelor în perioada 15 – 17 decembrie 2018 Drumul Naţional 1- Alba Iulia – Sântimbru …

Avertizare ANM. Cod PORTOCALIU de NINSORI abundente, GER şi VISCOL în opt judeţe
evz.ro - Bucureşti
Administraţia Naţională de Meteorologie a emis o avertizare Cod portocaliu de ninsori abundente şi viscol valabilă în opt judeţe, începând de sâmbătă, ora 6...

AJOFM Neamţ: 120 NOI locuri de muncă, comunicate în săptămâna 10-14 decembrie
www.stiri-neamt.ro - Neamţ
Agenţia Judeţeană pentru Ocuparea Forţei de Muncă Neamţ a publicat lista celor 120 locuri de muncă vacante NOI, comunicate în perioada 10-14 decembrie

Tulcea. Ce dezastru a putut sa provoace explozia unei butelii. De neimaginat
www.ziuaconstanta.ro - Constanţa
Explozie la Tulcea

Meteo. Starea drumurilor sub viscol. Ce drumuri sunt închise.
evz.ro - Bucureşti
Meteo şi INFOTRAFIC. Ce drumuri sunt închise la ora 7:00 în România, după instalarea Codului Portocaliu. Ameninţarea viscolului....

De ce e important să le citim copiilor când sunt mici
info.oradesibiu.ro - Sibiu
Este cunoscut faptul că cititul, atunci când suntem mici, ne dezvoltă imaginaţia, capacitatea de concentrare, dar şi creativitatea. Până când copiii vor creşte şi vor descoperi singuri magia lecturii însă, este bine ca părinţii să le citească seară de seară. Cititul încurajează setea de cunoaştere În cărţi există numeroase informaţii…

România, o ţară călcată în picioare de Rusia şi otrăvită sistematic cu minciuni! Opinie de Adrian Pătruşcă
evz.ro - Bucureşti
România a fost învinsă la Campionatul European de handbal de către Rusia. În semifinale. Un nou prilej de insatisfacţie. Dar şi de reflecţii amare. ...

Seara românească de la Besançon, un adevărat succes. Francezii s-au delectat cu sarmale (FOTO)
www.timponline.ro - Bistriţa-Năsăud
Chefii Nina Rus şi Mihaela Tatiana Ulhman au reuşit să-i impresioneze pe francezii din Besançon cu meniurile tradiţionale româneşti pe care le-au pregătit în bucătăria Lycée Condé împreună cu elevi de la Liceul de Servicii Bistriţa şi colegi ai lor francezi. Seara românească, organizată în cadrul pr

Trimitem din nou oi şi vaci pentru arabi. De când se reiau exporturile
www.timponline.ro - Bistriţa-Năsăud
Veşti bune pentru fermierii din judeţ. Se reiau exporturile de oi şi vaci către ţările arabe. Chiar în prima parte a anului 2019, vor pleca de la noi 100.000 de capete de oi şi 10.000 de bovine către ţările din Golful Persic, contractele fiind deja semnate.
Secretarul de stat Sorin Roşu Mareş de

Povestea unui CĂLAU care şi-a mâncat VICTIMA. Reporter de Cursă Lungă
evz.ro - Bucureşti
De dimineaţă a decapitat-o cu sânge rece şi, câteva ore mai târziu, a mâncat-o, pofticios, cu pilaf...

Firmele şi PFA-urile vor primi bani să angajeze tineri în agricultură şi în industria alimentară
www.timponline.ro - Bistriţa-Năsăud
Angajatorii din agricultură, acvacultură şi industria alimentară vor primi lunar bani de la stat dacă încadrează în muncă tineri în vârstă de cel mult 40 de ani, spune secretarul de stat Sorin Roşu Mareş de la Ministerul Agriculturii şi Dezvoltării Rurale. Măsura face parte dintr-un program de stimu

Raport DRDP Constanta. Cum se circula pe drumurile nationale si autostrazi. Unde ninge. Unde este zapada pe carosabil
www.ziuaconstanta.ro - Constanţa
DRDP Constanta

Cele mai frumoase exemplare de iepuri de casă, găini şi porumbei, într-o expoziţie la Şcoala „Avram Iancu” (FOTO)
www.timponline.ro - Bistriţa-Năsăud
Cele mai frumoase exemplare de iepuri de casă, porumbei şi găini şi iepuri de casă pot fi admirate până duminică la sala de sport a Şcolii Gimnaziale "Avram Iancu" din Bistriţa unde are loc a şaptea ediţie a expoziţiei organizată de Asociaţia crescătorilor de animale mici de blană şi păsări Bistriţa

Ecaterina Andronescu: Zeci de mii de profesori vor învăţa cum să predea digital la ore, pentru că suntem în secolul XXI
ziarulunirea.ro - Alba
Anunţul a fost făcut de ministrul Educaţiei, Ecaterina Andronescu, care a anunţat că în această etapă de formare vor intra 55.000 de profesori. „Avem deja un proiect în care 55.000 de profesori vor intra într-un proces de formare profesională şi sub aspect pedagogic şi sub aspect ştiinţific al disciplinei pe care o predau, dar şi …

„O cană de fericire” pe pietonalul Liviu Rebreanu. Pe cine sunt adunaţi banii din donaţii (FOTO)
www.timponline.ro - Bistriţa-Năsăud
"O cană de fericire" îi aşteaptă pe cei care trec pe pietonalul Liviu Rebreanu unde echipa Rotaract Club Bistriţa, alături de Interact Bistriţa-Nosa şi Rotary Club Bistriţa, vă invită să vă încălziţi mâinile cu o cană de vin fiert sau ceai fierbinte şi sufletul cu o faptă bună!
Proiectul O c

Revista presei locale
www.ziuaconstanta.ro - Constanţa
Revista presei locale

9 tradiţii de Crăciun din jurul lumii
www.7est.ro - Iaşi
%

Cum să îţi protejezi bradul de Crăciun de pisici şi câini? 30 de idei geniale
www.7est.ro - Iaşi
%

Reguli noi în construcţii. Ce nu trebuie să lipsească la o casă nouă
www.7est.ro - Iaşi
%

Brigitte Sfăt angajează vânzător la magazinul ei de haine! Vezi ce salariu oferă fosta soţie a lui Ilie Năstase!
www.7est.ro - Iaşi
%

SCUMPIRI în lanţ, de la 1 ianuarie. Energia electrică dă startul
www.7est.ro - Iaşi
%

Doar ele o «bat» pe Esca la decolteu! Ştiristele cu cei mai mari sâni naturali
www.7est.ro - Iaşi
%

Se strică vremea în weekend! Cod portocaliu de ninsori emis de meteorologi! Care sunt zonele unde va ninge abundent
www.7est.ro - Iaşi
%

Povestea incredibilă a unui bărbat care trăieşte cu două iubite: ”Vrem să ne căsătorim toţi trei!”
www.7est.ro - Iaşi
%

VIDEO: Imagini emotionante cu un motan salbatic ce a devenit bunicul ideal pentru pui de pisica orfani
www.7est.ro - Iaşi
%

Top cele mai frumoase orase din lume
www.7est.ro - Iaşi
%

Horoscop 2019. Ce zodii şi în ce perioadă pot primi veşti foarte bune, în anul 2019. Horoscop
evz.ro - Bucureşti
Horoscop Am alocat destul de mult timp pentru calcule şi documentare, am folosit programul ”Expert Astrologer 7.1”, Efemeridele NASA şi Swiss Astrodienst, ...

![60 de intervenţii în judeţul Timiş! Accidente, copaci căzuţi şi localităţi fără curent! Echipajele de deszăpezire din Timişoara nu fac faţă! [VIDEO]](/showimg/300-200--zi/images/fullinfo.ro-images/news-287910.jpg)




![De toată jena! Maşinile de deszăpezire au rămas înzăpezite la Lugoj! [VIDEO]](/showimg/300-200--zi/images/fullinfo.ro-images/news-287905.jpg)



























































































































































































































































































































































































































































